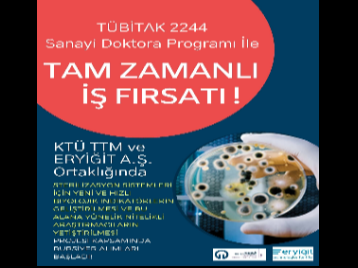
TÜBİTAK 2244 Sanayi Doktora Programı İle Tam Zamanlı İş Fırsatı! Başvurular 4 Eylüle Kadar Uzatıldı!

HAKKIMIZDA
YAYINLAR

Bilgi ve Deneyim Paylaşım Günleri
26 Haziran 2026

İş birliği olanakları ve proje fırsatlarına yönelik değerlendirme toplantısı gerçekleştirildi.
26 Haziran 2026

COST Programı Bilgilendirme Etkinliği
22 Haziran 2026

Bilgi ve Deneyim Paylaşım Günleri
22 Haziran 2026

Ziyarette proje süreçleri, patent, girişimcilik ve üniversite?sanayi iş birliği konuları ele alındı; ortak çalışmalar ve araştırma kapasitesi değerlendirildi.
17 Haziran 2026

Bilgi ve Deneyim Paylaşım Günleri
12 Haziran 2026

QUEST-Quadruple Helix-Based Enhancement of Stakeholders at Black Sea Territory
12 Haziran 2026

QUEST-Quadruple Helix-Based Enhancement of Stakeholders at Black Sea Territory Projesi
10 Haziran 2026

Merkezimiz faaliyetlerine yönelik Sağlık Bilimleri Fakültesine ziyaret gerçekleştirildi.
09 Haziran 2026

Bilgi ve Deneyim Paylaşım Günleri
05 Haziran 2026

RATIONE DIVIDE AI firması ile ulusal ve uluslararası iş birliği fırsatlarının değerlendirilmesine yönelik istişare toplantısı gerçekleştirildi.
04 Haziran 2026

Gerçekleştirilen etkinlikte katılımcılar, program sürecinde karşılaştıkları soruları yönelterek uygulamaya yönelik bilgi edinme imkânı buldu.
04 Haziran 2026

Toplantı Trabzon Arsin Organize Sanayi Bölgesi'nde düzenlenendi.
04 Haziran 2026

KTÜ TTM 2026 Mayıs Bülteni
04 Haziran 2026

Trabzon Tersanesi Gemi İnşa Bakım Onarım San. ve Tic. A.Ş. ve Prof. Dr. Ayfer DÖNMEZ ÇAVDAR ile görüşmeler gerçekleştirdi.
03 Haziran 2026

QUEST-Quadruple Helix-Based Enhancement of Stakeholders at Black Sea Territory
22 Mayıs 2026

Bilgi ve Deneyim Paylaşım Günleri
22 Mayıs 2026

TÜBİTAK BİDEB 2237-A Bilimsel Eğitim Etkinliklerini Destekleme Programı
15 Mayıs 2026

Bilgi ve Deneyim Paylaşım Günleri
15 Mayıs 2026

2026 Nisan BĂĽlteni
13 Mayıs 2026

Merkezimiz koordinasyonunda; Sağlık Bilimleri Enstitüsü, Fen Bilimleri Enstitüsü ile Yapay Zekâ ve Veri Uygulama ve Araştırma Merkezi iş birliğinde düzenlendi.
13 Mayıs 2026

SAHA EXPO 2026
11 Mayıs 2026

Bilgi ve Deneyim Paylaşım Günleri Gerçekleştirildi
11 Mayıs 2026

Merkezimiz Tarafından TÜBİTAK 2209-A/B Üniversite Öğrencileri Araştırma Projeleri Destekleme Programı Eğitimi Gerçekleştirildi
06 Mayıs 2026

TÜBİTAK 2237-A Programı
30 Nisan 2026

Her Patent Bir Fidana Dönüşüyor
29 Nisan 2026

Üniversite iş dünyası iş birliği fırsatlarının değerlendirilmesine yönelik toplantı gerçekleştirildi.
24 Nisan 2026

Bilgi ve Deneyim Paylaşım Günleri
24 Nisan 2026

Merkezimiz, DOKKAF 2026 Kariyer Fuarı'na katılarak öğrenciler ve paydaşlarla buluştu; teknoloji transferi, girişimcilik ve iş birlikleri üzerine bilgilendirmeler gerçekleştirdi.
21 Nisan 2026

Karadeniz Teknoloji ve İnovasyon Günü: Yatırımcı Buluşmaları II
21 Nisan 2026

Bilgi ve Deneyim Paylaşım Günleri
20 Nisan 2026

Quadruple Helix-Based Enhancement of Stakeholders at Black Sea Territory (QUEST) Projesi
17 Nisan 2026

"KTÜ TTM OSB Günleri" etkinliği, 14 Nisan 2026 tarihinde Trabzon Beşikdüzü Organize Sanayi Bölgesi'nde gerçekleştirildi.
15 Nisan 2026

Bilgi ve Deneyim Paylaşım Günleri
10 Nisan 2026

2026 Mart BĂĽlteni
09 Nisan 2026

Bilgi ve Deneyim Paylaşım Günleri
03 Nisan 2026

QUEST Projesi kapsamında düzenlenen "Üniversite Kümesi 1. Çevrimiçi Çalıştayı", farklı ülkelerden üniversitelerin katılımıyla fon erişimi ve iş birliği konularında gerçekleştirildi.
01 Nisan 2026

Merkezimiz bünyesinde, TÜBİTAK 1812 BİGG Yatırım Programı'nın 2026-1 dönemi birinci aşama hızlandırıcı faaliyetleri başladı.
01 Nisan 2026

Bilgi ve Deneyim Paylaşım Günleri
27 Mart 2026

Bilgi ve Deneyim Paylaşım Günleri
13 Mart 2026

2026 Ĺžubat BĂĽlteni
13 Mart 2026

Merkezimiz ile Nanomik Biyoteknoloji Anonim Şirketi arasında üniversite iş dünyası iş birliği kapsamında tanışma toplantısı gerçekleştirildi.
10 Mart 2026

Merkezimiz ile Kütahya Entegre Kağıt San. ve Ticaret A.Ş. arasında üniversite iş dünyası iş birliği kapsamında görüşme gerçekleştirildi.
09 Mart 2026

Bilgi ve Deneyim Paylaşım Günleri
09 Mart 2026

Merkezimiz ile Kahramanmaraş Kağıt Sanayi ve Ticaret A.Ş. arasında üniversite iş dünyası iş birliği kapsamında görüşme gerçekleştirildi.
09 Mart 2026

Merkezimiz ile Çilek Mobilya A.Ş. arasında üniversite iş dünyası iş birliği kapsamında bir tanışma toplantısı gerçekleştirildi.
09 Mart 2026

Bilgi ve Deneyim Paylaşım Günleri
27 Ĺžubat 2026

Erasmus+ Proje Geliştirme Mentörlük Günleri
25 Ĺžubat 2026

Bilgi ve Deneyim Paylaşım Günleri
20 Ĺžubat 2026

ETİ Bakır A.Ş.
20 Ĺžubat 2026

Erasmus+ Proje Geliştirme Mentörlük Günleri
20 Ĺžubat 2026

Merkezimiz tarafından araştırmacılara yönelik bilgilendirme etkinliği düzenlendi.
18 Ĺžubat 2026

Erasmus+ Proje Geliştirme Mentörlük Günleri
17 Ĺžubat 2026

Yeni KTÜ'lü Araştırmacılara Yönelik Başlangıç Eğitimi
17 Ĺžubat 2026

Proje fikri geliştirme toplantısı
17 Ĺžubat 2026

Akçasaray Et Ürünleri ile merkezde eşleştirme toplantısı yapıldı; akademisyen ve uzmanların katılımıyla planlanan projeler görüşüldü.
16 Ĺžubat 2026

Bilgi ve Deneyim Paylaşım Günleri
13 Ĺžubat 2026

Görüşmenin, kurumlar arası iş birliğinin güçlendirilmesine, iş dünyası ile üniversite odaklı ulusal ve uluslararası ortak proje geliştirme süreçlerine katkı sağlaması hedeflenmektedir.
12 Ĺžubat 2026

KUMTEL Dayanıklı Tüketim Malları Plastik San. ve Tic. A.Ş.
11 Ĺžubat 2026

Gerçekleştirilen görüşmenin, üniversiteler arası iş birliğinin geliştirilmesine ve ortak proje geliştirme süreçlerine yönelik adımların atılmasına katkı sağlaması hedeflenmektedir.
10 Ĺžubat 2026

TÜBİTAK ARDEB 1001 Programı Bilgilendirme ve Mentörlük Günleri
10 Ĺžubat 2026

Bilgi ve Deneyim Paylaşım Günleri
06 Ĺžubat 2026

Erasmus+ Proje Geliştirme Mentörlük Günleri
06 Ĺžubat 2026

SoGreen Sosyal Fayda Perspektifiyle Yeşil Dönüşüm Buluşması
04 Ĺžubat 2026

TÜBİTAK ARDEB 1001 Programı Bilgilendirme ve Mentörlük Günleri
04 Ĺžubat 2026

2026 Ocak BĂĽlteni
03 Ĺžubat 2026

Erasmus+ Proje Geliştirme Mentörlük Günleri
30 Ocak 2026

Bilgi ve Deneyim Paylaşım Günleri
30 Ocak 2026

Etkinlikte TÜBİTAK 1001 Programı?nın kapsamı, çağrı takvimi, proje başvuru sürecinde dikkat edilmesi gereken hususlar ve genel başvuru kuralları ele alındı.
29 Ocak 2026

Mentörlük günleri hakkında detaylı bilgi için Merkezimiz ile iletişime geçebilirsiniz.
28 Ocak 2026

Bilgi ve Deneyim Paylaşım Günleri
23 Ocak 2026

Mentörlük günleri hakkında detaylı bilgi için Merkezimiz ile iletişime geçebilirsiniz.
21 Ocak 2026

TÜBİTAK 1001 Bilimsel ve Teknolojik Araştırma Projelerini Destekleme Programı
20 Ocak 2026

Bilgi ve Deneyim Paylaşım Günleri
16 Ocak 2026

Tanışma Toplantısı
16 Ocak 2026

Proje Geliştirme Eğitim ve Mentörlük Günler
15 Ocak 2026

Merkezimiz ile Şinik OSB'de faaliyetlerini yürüten Akçasaray Et Ürünleri ve Tic. Ltd. Şti. arasında üniversite iş dünyası iş birliği kapsamında ziyaret gerçekleştirildi.
15 Ocak 2026

Merkezimiz ile Üçgen Dekorasyon Alüminyum PVC Cam Ahşap San. Tic. Ltd. Şti. arasında üniversite iş dünyası iş birliği kapsamında toplantı gerçekleştirildi.
13 Ocak 2026

Bilgi ve Deneyim Paylaşım Günleri
09 Ocak 2026

Erasmus+ Programı Proje Geliştirme Eğitim ve Mentörlük Günleri
07 Ocak 2026

KTÜ Performans Yönetim Sistemi
06 Ocak 2026

Proje Geliştirme Eğitim ve Mentörlük Günleri
05 Ocak 2026

Taraflar, ortak hedefler doğrultusunda sürdürülebilir ve tamamlayıcı çalışmalar yürütme konusunda görüş birliğine vardı.
05 Ocak 2026

Fiziksel Dörtlü Sarmal Çalıştayı
26 Aralık 2025

Bilgi ve Deneyim Paylaşım Günleri
26 Aralık 2025

Kayıkçıoğlu Klima ve Soğutma A.Ş. firması yerinde ziyaret edildi.
26 Aralık 2025

TÜBİTAK 1812 Yatırım Tabanlı Girişimcilik Destek Programı (BiGG Yatırım)
24 Aralık 2025

Polifish Deniz ve Su Ürünleri firması ile KTÜ bünyesinde faaliyet gösteren ProFit Araştırma Ekibi eşleştirilmiştir.
22 Aralık 2025

Bilgi ve Deneyim Paylaşım Günleri
19 Aralık 2025

2025 Kasım Bülteni
18 Aralık 2025

Karadeniz Havzası için Ulusötesi Teknoloji Transfer Ağı (Transnational Technology Transfer Network for the Black Sea Basin T3N-BSB)
17 Aralık 2025

Grand Black Sea Forum
12 Aralık 2025

Grand Black Sea Forum
11 Aralık 2025

Grand Black Sea Forum
10 Aralık 2025

Üniversite iş dünyası iş birliği kapsamında Üçgen Dekorasyon Alüminyum Pvc Cam Ahşap San. Tic. Ltd. Şti. firması ile toplantı gerçekleştirildi.
08 Aralık 2025

Bilgi ve Deneyim Paylaşım Günleri
05 Aralık 2025

KTÜ TTM Tarafından Orman Endüstri Mühendisliği Lisans Öğrencilerine Yönelik Destek Programları Eğitimi Gerçekleştirildi
04 Aralık 2025

KTÜ TTM ve Orman Fakültesi İş Birliğiyle "Disiplinler Arası Lisans Proje Hazırlama Etkinliği 2025" Kapsamında Proje Yazma Eğitimi Gerçekleştirildi
04 Aralık 2025

Eşleştirme ve Projelendirme Toplantısı
02 Aralık 2025

Bilgi ve Deneyim Paylaşım Günleri
28 Kasım 2025

ÜSİMP ULUSAL Kongresi, Fuarı ve Sempozyumu"
28 Kasım 2025

Bluvax Medya Hizmetleri Tic. Ltd. Şti.?ye ziyaret gerçekleştir
26 Kasım 2025

2025 Yılı İç ve Dış Paydaş Toplantıları
26 Kasım 2025

Bilgi ve Deneyim Paylaşım Günleri
21 Kasım 2025

TÜBİTAK 1831 Programı kapsamında yapılan ziyaretler, bölge firmalarının yenilikçi, çevreci ve verimli üretim süreçlerine katkı sunmayı amaçlamaktadır.
17 Kasım 2025

Bilgi ve Deneyim Paylaşım Günleri
14 Kasım 2025

Erasmus+ KA2 (Kurum ve Kuruluşlar Arasında İşbirliği) Eylemi
13 Kasım 2025

TÜBİTAK 2209 A/B Programları Uygulamalı Eğitimi, 6?7 Kasım 2025 tarihlerinde gerçekleştirildi.
12 Kasım 2025

Bilgi ve Deneyim Paylaşım Günleri
07 Kasım 2025

İş Birliği ve Deneyim Toplantısı
07 Kasım 2025

2025 Ekim BĂĽlteni
07 Kasım 2025

Eğitim, KTÜ Teknoloji Transferi Uygulama ve Araştırma Merkezi (KTÜ TTM) Girişimcilik ve Ticarileşme Hizmetleri Koordinatörü Proje Uzmanı Eren YILMAZ tarafından gerçekleştirildi.
05 Kasım 2025

Quadruple Helix-Based Enhancement of Stakeholders at Black Sea Territory - QUEST
03 Kasım 2025

TÜBİTAK 2209 programları hakkında daha fazla bilgi ve proje başvurularında destek almak isteyen öğrenciler, KTÜ TTM ile iletişime geçebilirler.
31 Ekim 2025

Bilgi ve Deneyim Paylaşımı
31 Ekim 2025

Etkinlikler kapsamında, 24 Ekim 2025 tarihinde Biyoloji Bölümü öğrencileriyle, 27 Ekim 2025 tarihinde ise Edebiyat Fakültesi öğrencileriyle bir araya gelindi.
28 Ekim 2025

TÜBİTAK 2209-A Üniversite Öğrencileri Araştırma Projeleri Desteği Programı ile 2209-B Sanayiye Yönelik Araştırma Projeleri Desteği Programı hakkında detaylı bilgiler paylaşıldı.
28 Ekim 2025

Bilgi ve Deneyim Paylaşım Günleri
24 Ekim 2025

Strengthening Technology Transfer Ecosystem through Innovative and Digital Approaches (STEIDA)
24 Ekim 2025

Bilgilendirme Etkinliği KTÜ TTM Proje Uzmanı Güler Tuğba GÜLTEKİN tarafından gerçekleştirildi.
24 Ekim 2025

Mühendislik Fakültesi 4. Öğrenci Buluşması Etkinliği
23 Ekim 2025

Ortahisar Belediye BaĹźkan Danışmanı Ahmet Ä°hsan HACIFETTAHOÄžLU KTĂś TTM MĂĽdĂĽrĂĽ Ă–Äźr. Gör. Emrah AYVAZ'a ziyarette bulundu.Â
22 Ekim 2025

Bilgi ve Deneyim Paylaşım Günleri
17 Ekim 2025

Trabzon Tersanesi Gemi İnşa Bakım Onarım San. ve Tic. A.Ş. Ziyareti
17 Ekim 2025

Giresun Üniversitesi Teknoloji Transfer Ofisi'nden (TTO) Gökçe Nur Polat, KTÜ TTM yönetimine ziyarette bulundu.
16 Ekim 2025

18. Uluslararası Teknoloji Transfer Konferansı
15 Ekim 2025

Doğu Karadeniz Kalkınma Ajansı (DOKA) Genel Sekreteri Kemal AKPINAR, KTÜ TTM Müdürü Öğr. Gör. Emrah AYVAZ'ı Ziyaret Etti.
14 Ekim 2025

STEAMFEST Trabzon ? Bilimle BĂĽyĂĽyen Zihinler
13 Ekim 2025

Bilgi ve Deneyim Paylaşım Günleri
13 Ekim 2025

Sanayi Odaklı Ar-Ge Projeleri için TÜBİTAK 1505 Üniversite-Sanayi İş Birliği Destek Programı Başvuru ve Yazım Süreçleri
13 Ekim 2025

KTÜ TTM ve Heyelan UYGAR Arasında Proje Geliştirme Toplantısı Gerçekleştirildi
08 Ekim 2025

KTÜ TTM ve Trabzon İl Sağlık Müdürlüğü Proje Uzmanları Arasında İş Birliği Toplantısı Gerçekleştirildi
08 Ekim 2025

AB Fonlarına Erişimi Kolaylaştıran Yeni Mobil Uygulama: EU Funding&Me
06 Ekim 2025

Eğitmen Proje Uzmanı Güler Tuğba GÜLTEKİN, öğrencilere proje başvuruları, girişimcilik destek mekanizmaları ve üniversite içerisinde erişilebilecek imkânlar konusunda bilgiler aktardı.
03 Ekim 2025

Bilgi ve Deneyim Paylaşım Günleri
03 Ekim 2025

Eylül Ayı İçinde COST Aksiyonuna Atanan Araştırmacılarımıza Tebrik
30 EylĂĽl 2025

Uluslararası Mobilya Yan Sanayi, Aksesuarları, Orman Ürünleri ve Ahşap Teknolojisi Fuarı "İntermob 2025"
29 EylĂĽl 2025

Karadeniz Teknik Üniversitesi Teknoloji Transferi Uygulama ve Araştırma Merkezi ile Dış İlişkiler Genel Koordinatörlüğü iş birliğinde düzenlendi.
25 EylĂĽl 2025

Yarışmadaki ilk 20 buluş, ödül almaya hak kazanırken Üniversitemizin lisansüstü öğrencileri 2. ve 15.'lik Ödülü'nü almaya hak kazandı.
23 EylĂĽl 2025

10. İstanbul Uluslararası Buluş Fuarı
22 EylĂĽl 2025

Üniversitemize ait sınai mülkiyet varlıklarının ticarileşmesine katkı sağlamak amacıyla fuar süresince ziyaretçilere tanıtımlarını sürdürmekteyiz.
18 EylĂĽl 2025

Üniversitemizin fikri ve sınai mülkiyet havuzunda bulunan patentlerden 10?u fuarda sergilemektedir.
17 EylĂĽl 2025

Toplantıda, bölgenin kalkınmasına katkı sağlayacak yaratıcı proje önerilerinin geliştirilmesi için başvuruya açık olan Sıfır Atık Hibe Programı ile ilgili görüşler paylaşıldı.
17 EylĂĽl 2025

TÜBİTAK ARDEB 1001 Programı 2025 Yılı 2. Çağrı Dönemi kapsamında düzenlenen ?Bilgilendirme ve Mentörlük Günleri? tamamlandı.
16 EylĂĽl 2025

Bilgilendirme ve Mentörlük Günleri
11 EylĂĽl 2025

''Bilgilendirme ve Mentörlük Günleri'' TÜBİTAK ARDEB 1001 Programı 2025 Yılı 2. Çağrı Dönemi kapsamında düzenlenmiştir.
09 EylĂĽl 2025

KTÜ TTM, Arsin Organize Sanayi Bölgesi'nde savunma sanayinde faaliyet gösteren TİSAŞ Trabzon Silah Sanayi A.Ş.'yi ziyaret etti.
09 EylĂĽl 2025

AÄźustos BĂĽlteni
03 EylĂĽl 2025

Trabzon Büyükşehir Belediyesi, Akçaabat Belediyesi ve KTÜ TTM uzmanlarının katılımıyla proje fikri geliştirme toplantısı organize edilmiştir.
29 AÄźustos 2025

Ağustos Ayı İçinde COST Aksiyonuna Atanan Araştırmacılarımıza Tebrik
29 AÄźustos 2025

KTÜ TTM, Şinik Organize Sanayi Bölgesi'nde faaliyet gösteren Smogmoon Tabacco Tütün Mam. San. Tic. Ltd. Şti. ve Sözenler San. ve Tic. A.Ş. firmalarını ziyaret etti.
29 AÄźustos 2025

TÜBİTAK ARDEB 1001 Programı hakkında ayrıntılı bilgiler paylaşıldı ve araştırmacılara proje başvuru süreçlerinde dikkat edilmesi gereken hususlar aktarıldı.
28 AÄźustos 2025

Gerçekleştirilen ziyaretlerde, üniversite iş dünyası iş birliğinin olanakları ele alındı.
28 AÄźustos 2025

KA220 İş Birliği Ortaklıkları'na Üniversitemiz yürütücülüğünde gerçekleştirilen başvurular arasından iki proje destek almaya hak kazanmıştır.
27 AÄźustos 2025

Proje Geliştirme Toplantısı
20 AÄźustos 2025

KTÜ TTM Trabzon Sanayi ve Teknoloji İl Müdürlüğü iş birliğiyle Şinik Organize Sanayi Bölgesi'nde bilgilendirme etkinliği gerçekleştirdi.
19 AÄźustos 2025

Üniversite iş dünyası iş birliği faaliyetleri kapsamında POLIFISH'e yerinde ziyaret düzenlenerek iş birlikleri hakkında görüşmeler gerçekleştirildi.
14 AÄźustos 2025

Plaket, Merkezimiz adına Rektör Yardımcısı ve Merkezimiz Yönetim Kurulu Başkanı Prof. Dr. Ömer Faruk URSAVAŞ'a takdim edildi.
14 AÄźustos 2025

Transnational Technology Transfer Network for the Black Sea Basin (T3N-BSB)
11 AÄźustos 2025

2025 Temmuz BĂĽlteni
11 AÄźustos 2025

Gerçekleştirilen görüşmede, Trabzon?daki sanayi işletmelerine yönelik iş birliği olanakları ele alındı.
08 AÄźustos 2025

Bu dönem içerisinde üniversitemizden TÜBİTAK 1001 programında 6 proje desteklenmeye hak kazanmıştır.
06 AÄźustos 2025

T3N-BSB projesi kapsamında geliştirilen yenilikçi dijital platform T3N BSB Portalı resmî olarak Temmuz 2025 itibarıyla kullanıma sunulmuştur.
06 AÄźustos 2025

Etkinlik, girişimcilik ekosistemine yönelik farkındalık oluşturmak ve iş dünyası ile üniversite arasında köprü kurmak amacıyla düzenlendi.
06 AÄźustos 2025

Karadeniz Havzası için Ulusötesi Teknoloji Transfer Ağı (T3N-BSB)
01 AÄźustos 2025

COST Aksiyonuna Atanan Araştırmacılarımıza Tebrik
31 Temmuz 2025

Çeşitli proje destek programları ile hâlihazırda yürütülen projelerde aktif görev alarak öğreniminizi uygulamalı biçimde pekiştirebileceğiniz pek çok fırsat sunulmaktadır.
28 Temmuz 2025

KTĂś TTM MĂĽdĂĽrĂĽ Ă–Äźr. Gör. Emrah AYVAZ ve MĂĽdĂĽr Yardımcısı Ă–Äźr. Gör. Ä°slam YILDIZ, KOSGEB Trabzon MĂĽdĂĽrĂĽ Hakan Demirci?yi makamında ziyaret etti.Â
25 Temmuz 2025

Interreg NEXT Karadeniz Havzası için Ulusötesi Teknoloji Transfer Ağı (T3N-BSB) Projesi
22 Temmuz 2025

Lisansüstü Öğrencilerine Yönelik Patent Araştırma Yetkinliklerinin Arttırılması Eğitimi
14 Temmuz 2025

''2025 TTO Çalıştayı''na KTÜ TTM adına Öğr. Gör. İslam YILDIZ ve Öğr. Gör. Gözde SAĞLAM temsilci olarak katıldı.
04 Temmuz 2025

Haziran BĂĽlteni
04 Temmuz 2025

''Karadeniz Havzası için Ulusötesi Teknoloji Transfer Ağı (T3N-BSB)'' Projesi
03 Temmuz 2025

Ă–Äźrencilerimiz aldıkları desteklerle projeler yoluyla araĹźtırma yapmaya teĹźvik edilmekte ve araĹźtırma ekosistemine dahil olmaktadırlar.Â
01 Temmuz 2025

COST Aksiyonuna Atanan Araştırmacılarımıza Tebrik
01 Temmuz 2025

Ekim'de görüşmek üzere.
30 Haziran 2025

5 girişimcimiz destek almaya hak kazanmıştır.
30 Haziran 2025

Akademik bilgi ve deneyimlerin paylaşımına katkı sunan tüm katılımcılarımıza teşekkür ederiz!
30 Haziran 2025

Bilgi ve Deneyim Paylaşım Günleri
27 Haziran 2025

Bilgi ve Deneyim Paylaşım Günleri
20 Haziran 2025

"Sürdürülebilir Bir Geleceğe Doğru: Duyarlı Girişimciler Okulu" projesinde lise öğrencilerine yönelik uygulamalı girişimcilik eğitimi gerçekleştirdi.
19 Haziran 2025

Bilgi ve Deneyim Paylaşım Günleri
16 Haziran 2025

COST Programı Kapsamında 70 Yeni Aksiyon MC ve WG Başvurularına Açıldı!
12 Haziran 2025

Mayıs Bülteni
04 Haziran 2025

COST Aksiyonuna Atanan Araştırmacılarımıza Tebrik
02 Haziran 2025

Bilgi ve Deneyim Paylaşım Günleri
30 Mayıs 2025

Firmaların tanıtım sunumlarını gerçekleştirmelerinin ardından firma akademisyen B2B görüşmeleri yapıldı.
29 Mayıs 2025

Trabzon Tersanesi Gemi İnşa Bakım Onarım San. ve Tic. A.Ş.'ye ziyaret gerçekleştirildi.
29 Mayıs 2025

Eğitimde, TÜBİTAK ARDEB programlarının kapsamı, başvuru aşamasında dikkat edilmesi gereken hususlar ile destek türleri hakkında katılımcılara ayrıntılı bilgiler sunuldu.
28 Mayıs 2025

Bilim, Kültür, Sanat Haftası (BKS 2025)
26 Mayıs 2025

KTÜ TTM olarak, etkinliğe katılım sağlayan tüm akademisyenlerimize ve iş birliği süreçlerine katkı sunan ASELSAN yetkililerine teşekkür ederiz.
26 Mayıs 2025

Bilgi ve Deneyim Paylaşım Günleri
23 Mayıs 2025

Söz konusu Aksiyonlarla ilgili detaylar ve Aksiyon Mutabakat Zabıtları (Memorandum of Understanding) 12 Haziran 2025 tarihi itibariyle COST web sayfasında yayınlanacaktır.
21 Mayıs 2025

"Doğu Karadeniz Yeşil İnovasyon Ağı" projesinin ilk paydaş toplantısı KTÜ TTM?de gerçekleştirildi.
20 Mayıs 2025

Bilgi ve Deneyim Paylaşım Günleri
16 Mayıs 2025

Bilgi ve Deneyim Paylaşım Günleri
09 Mayıs 2025

Bakır-Çinko Sanayi ve Tic. A.Ş. firmasına yerinde ziyaret yapıldı.
08 Mayıs 2025

DARICA UN firması yerinde ziyaret edilerek yalın dönüşüm süreçlerine yönelik ön değerlendirme ve proje planlama toplantısı gerçekleştirildi.
06 Mayıs 2025

Doğu Karadeniz Yeşil İnovasyon Ağı
06 Mayıs 2025

Nisan BĂĽlteni
05 Mayıs 2025

TÜBİTAK'ın lisans öğrencilerine yönelik destek programları hakkında kapsamlı bilgiler sunuldu.
02 Mayıs 2025

COST Aksiyonuna Atanan Araştırmacılarımıza Tebrik
30 Nisan 2025

Toplantıda, proje ortakları tarafından geliştirilen "Teknoloji Transfer Süreçlerine Odaklanan Kapasite Geliştirme Eğitim Modülleri"nin nihai içerikleri üzerinde mutabakata varıldı.
29 Nisan 2025

Bilgi ve Deneyim Paylaşım Günleri
25 Nisan 2025

KTÜ Teknoloji Transferi Uygulama ve Araştırma Merkezi (KTÜ TTM), Dünya Fikri Mülkiyet Günü ve Patent Haftası kapsamında anlamlı bir etkinliğe ev sahipliği yaptık.
24 Nisan 2025

Yoğun ilgi ve yüksek etkileşimle tamamlanan etkinlik, bölgedeki akademik bilgi birikiminin ticarileşmesine yönelik önemli bir adım oldu.
22 Nisan 2025

Bilgi ve Deneyim Paylaşım Günleri
18 Nisan 2025

"KTÜ TTM İrtibat Temsilcileri" grubunun 2025 yılı itibariyle yenilenen üyeleri ile ilk toplantı gerçekleştirildi.
18 Nisan 2025

KTÜ TTM ve TÜBİTAK iş birliğiyle 16-17 Nisan 2025 tarihlerinde Üniversitemizde düzenlenen "Ufuk Avrupa Proje Yazma Eğitimi", araştırmacılarımızın aktif katılımıyla başarıyla tamamlandı.
18 Nisan 2025

TÜBİTAK ARDEB tarafından yürütülen 1002-Hızlı Destek Programı kapsamında yapılacak iyileştirmeler sebebiyle 28 Nisan 2025 itibariyle mevcut formlarla başvuru alınmayacaktır.
18 Nisan 2025

Projesi desteklenen akademisyenimizi ve proje ekibini tebrik eder, başarılarının devamını dileriz.
17 Nisan 2025

Ufuk Avrupa Bilgi GĂĽnĂĽ
17 Nisan 2025

Trabzon Arsin Organize Sanayi Bölgesi?nde (Arsin OSB)
17 Nisan 2025

2025 Mart BĂĽlteni
14 Nisan 2025

Bilgi ve Deneyim Paylaşım Günleri
11 Nisan 2025

Üniversitemiz Başvuruda 10. Tescilde 14. Sırada
10 Nisan 2025

TÜBİTAK 2209/A Programı 410 Başvurudan 253 Kabul TÜBİTAK 2209/B Programı 52 Başvurudan 27 Kabul
09 Nisan 2025

Disiplinlerarası İş Birliği: Ortak Bilimsel Çalışmalarla Yenilikçi Buluşlar ve Patent Koruma Süreçleri Bilgi ve Deneyim Paylaşımı
28 Mart 2025

COST Aksiyonuna Atanan Araştırmacılarımıza Tebrik
28 Mart 2025

Bilgi ve Deneyim Paylaşım Günleri
21 Mart 2025

Bilgi ve Deneyim Paylaşım Günleri
14 Mart 2025

Doğu Karadeniz Yeşil İnovasyon Ağı
11 Mart 2025

Bilgi ve Paylaşım Deneyim Günleri
10 Mart 2025

Bilgi ve Deneyim Paylaşım Günleri
28 Ĺžubat 2025

COŞT Aksiyonuna Atanan Araştırmacılarımıza Tebrik
28 Ĺžubat 2025

Mentörlük günleri hakkında detaylı bilgi için KTÜ TTM ile iletişime geçebilirsiniz.
27 Ĺžubat 2025

TÜBİTAK 2237-A Programı Lisans Öğrencilerinin Bilimsel Araştırma Projesi Hazırlama Kapasitesinin Artırılması-2
25 Ĺžubat 2025

KTÜ, 2024 yılı 2. döneminde toplamda 10 proje desteği ile %42 destek oranına ulaşmıştır.
24 Ĺžubat 2025

KTÜ TTM Müdürü Öğr. Gör. Emrah AYVAZ, TTSO Yönetim Kurulu Başkanı Erkut ÇELEBİ'yi makamında ziyaret etti.
24 Ĺžubat 2025

Bilgi ve Deneyim Paylaşım Günleri
21 Ĺžubat 2025

Mentörlük günleri hakkında detaylı bilgi için KTÜ TTM ile iletişime geçebilirsiniz.
17 Ĺžubat 2025

Bilgi ve Deneyim Paylaşım Günleri
17 Ĺžubat 2025

TÜBİTAK TEYDEB 1501 Sanayi Ar-Ge Projeleri Destekleme Programı
07 Ĺžubat 2025

Strengthening Technology Transfer Ecosystem through Innovative and Digital Approaches - STEIDA
07 Ĺžubat 2025

Fikri ve Sınai Mülkiyet Hakları Eğitimi
05 Ĺžubat 2025

Mentörlük günleri hakkında detaylı bilgi için KTÜ TTM ile iletişime geçebilirsiniz.
03 Ĺžubat 2025

COST Aksiyonuna Atanan Araştırmacılarımıza Tebrik
03 Ĺžubat 2025

TÜBİTAK TEYDEB 1507-KOBİ Ar-Ge Başlangıç Destek Programı
31 Ocak 2025

Projenin altıncı çevrim içi toplantısı tüm proje ortaklarının katılımıyla başarıyla gerçekleştirildi.
29 Ocak 2025

Toplantıda, POLIFISH'in ihtiyaçları doğrultusunda geliştirilebilecek projeler üzerine karşılıklı bilgi alışverişinde bulunulmuştur.
29 Ocak 2025

Development of Wood Science Master Programme (WOOD-MAS)
29 Ocak 2025

KTÜ Deprem ve Yapı Sağlığı UYGAR Müdürü Prof. Dr. Ahmet Can ALTUNIŞIK ve KTÜ Deprem ve Yapı Sağlığı UYGAR Müdür Yardımcısı Dr. Öğr. Üyesi Fatih Yesevi OKUR konuk olarak yer aldı.
27 Ocak 2025

Akademisyenlerimize "KTÜ Ekolü"ne sağladıkları katkılardan ötürü teşekkürlerimizi sunarız.
27 Ocak 2025

Erasmus+ Programı 2025 Yılı Başvuru Dönemi Proje Geliştirme Eğitim ve Mentörlük Günleri
24 Ocak 2025

Elsa Mühendislik Müşavirlik ve Ormancılık San. Tic. Ltd. Şti.
22 Ocak 2025

Erasmus+ Programı 2025 Yılı Başvuru Dönemi Proje Geliştirme Eğitim ve Mentörlük Günleri
21 Ocak 2025

Etkinlik katılımcıların sorularının cevaplanması ile tamamlandı.
17 Ocak 2025

Toplantı 2025 yılı için ortak hedefler doğrultusunda sonuç odaklı yaklaşımların derlenmesiyle sona erdi.
13 Ocak 2025

COST | European Cooperation in Science and Technology
10 Ocak 2025

Etkinlikte COST Aksiyonları hakkında değerli bilgiler sunulmuştur.
10 Ocak 2025

Kadın Konukevleri Hizmetlerinde İhtisaslaşmış Bir Yaklaşım: Güçlenme ve Etkin Destekle Verimli Entegrasyon - GÜVEN
09 Ocak 2025

Proje Fikri Geliştirme ve Proje Hazırlama Eğitimi
09 Ocak 2025

Trabzon Arsin Organize Sanayi Bölgesi (OSB)
08 Ocak 2025

2024 Aralık Ayı Bülteni
08 Ocak 2025

KA2-Kurum ve Kuruluşlar Arasında İş Birliği Projeleri (KA210 ve KA220) Bilgilendirme Etkinliği
03 Ocak 2025

TÜBİTAK 1001-Bilimsel ve Teknolojik Araştırma Projelerini Destekleme Programı 2024 Yılı 2. Dönemi
02 Ocak 2025

COST Aksiyonuna Atanan Araştırmacılarımıza Tebrik
02 Ocak 2025

Eğitime, KTÜ TTM personeli Öğr. Gör. Kerim Sönmez davetli konuşmacı olarak katılım sağladı.
02 Ocak 2025

Ziyaret kapsamında uluslararası projelerde ortaklık fırsatlarının değerlendirilmesi amacıyla görüşmeler gerçekleştirildi.
25 Aralık 2024

Teknoloji, Gelişim ve İş birliği Perspektifinden Türk Savunma Sanayisine Bakış
19 Aralık 2024

Programlar hakkında detaylı bilgi ve destek almak için KTÜ TTM ile iletişime geçebilirsiniz.
18 Aralık 2024

Bilgilendirme EtkinliÄźi
12 Aralık 2024

TĂśBÄ°TAK 1002-B Acil Destek ModĂĽlĂĽ
11 Aralık 2024

Programlar hakkında detaylı bilgi ve destek almak isteyen öğrencilerimiz KTÜ TTM ile iletişime geçebilir.
11 Aralık 2024

Eğitim öğrencilerin sorularının cevaplanması ile tamamlandı.
10 Aralık 2024

Tavan Aydınlatma Armatürü
10 Aralık 2024

5 farklı kurumdan toplamda 24 araştırmacının katılımıyla KTÜ TTM ev sahipliğinde gerçekleştirilmiştir.
10 Aralık 2024

Doktora Öğrencisi ve Çalışma Arkadaşları Aranıyor!
09 Aralık 2024

Startup Yatırım Zirvesi 2024 Etkinliği
06 Aralık 2024

Mühendislik Yapılarında Gerçek Zamanlı Dinamik Karakteristiklerin Otomatik Takip Yöntemi
06 Aralık 2024

Ăśniversite Sanayi Ä°Ĺź BirliÄźi
05 Aralık 2024

2024 Kasım Ayı Bülteni
05 Aralık 2024

Yerinde Yoğunluk Ölçer
04 Aralık 2024

Renkli İlaç İsimlikli Serum Yolu Düzenleyicisi
04 Aralık 2024

Bilgilendirme eğitimi Merkezimiz patent uzmanlarından Öğr. Gör. Hülya SABIR tarafından gerçekleştirilmiştir.
03 Aralık 2024

TÜBİTAK 1002-Hızlı Destek Programı
03 Aralık 2024

TÜBİTAK TEYDEB 1505 Üniversite Sanayi İş Birliği Destek Programı
02 Aralık 2024

TÜBİTAK 1002-Hızlı Destek Programı
29 Kasım 2024

COST Aksiyonuna atanan araştırmacılarımıza tebrik
29 Kasım 2024

1501-TÜBİTAK Sanayi Ar-Ge Projeleri Destekleme Programı
28 Kasım 2024

T3N-BSB Projesi
26 Kasım 2024

İç paydaş ve dış paydaş toplantıları TTM Seminer Salonunda gerçekleştirilmiştir.
26 Kasım 2024

Erasmus+ 2025 Yılı Teklif Çağrısı
25 Kasım 2024

TÜBİTAK 1509 TÜBİTAK Uluslararası Sanayi Ar-Ge Projeleri Destekleme Programı
20 Kasım 2024

TÜBİTAK 1501 Sanayi Ar-Ge Projeleri Destekleme Programı
20 Kasım 2024

TÜBİTAK 1812 Yatırım Tabanlı Girişimcilik Destek Programı
14 Kasım 2024

TĂśBÄ°TAK 1002 Proje DesteÄźi
12 Kasım 2024

Scale Up Your IP
08 Kasım 2024

TÜBİTAK 1501 Sanayi Ar-Ge Destek Programı
07 Kasım 2024

2024 Ekim Ayı Bülteni
06 Kasım 2024

COST Aksiyonuna Atanan Araştırmacılarımıza Tebrik
01 Kasım 2024

T3N-BSB Projesinin İlk Fiziki Toplantısı
01 Kasım 2024

Öğr. Gör. Emrah AYVAZ, KTÜ TTM Müdürlük Görevi Devraldı
31 Ekim 2024

Ăśniversite Sanayi Ä°Ĺź BirliÄźi
28 Ekim 2024

TĂśBÄ°TAK-2510 Tunus Ä°kili Ä°ĹźbirliÄźi Proje DesteÄźi
24 Ekim 2024

2-6 Ekim 2024 tarihlerinde Adana TEKNOFEST kapsamında düzenlenen 9. Uluslararası Buluş Fuarı'nda Üniversitemiz 10 Madalya kazanarak büyük başarı elde etti.
24 Ekim 2024

3. Öğrenci Buluşması
23 Ekim 2024

TĂśBÄ°TAK 1002 Proje DesteÄźi
23 Ekim 2024

T3N-BSB/Transnational Technology Transfer Network for Black Sea Basin Projesi
18 Ekim 2024

TĂśSEB Proje DesteÄźi
17 Ekim 2024

TĂśSEB Proje DesteÄźi
17 Ekim 2024

Ăśniversite-Sanayi Ä°Ĺź BirliÄźi
17 Ekim 2024

Lisans Öğrencilerine Yönelik TÜBİTAK 2209 Proje Hazırlama Eğitimi
16 Ekim 2024

TĂśBÄ°TAK 1001 Proje DesteÄźi
16 Ekim 2024

Üniversitemiz Öğretim Üyesi İnovasyon Ekosistemine Katkılarıyla Öne Çıkıyor
16 Ekim 2024

Ulusal Patent BaĹźvurusu
11 Ekim 2024

17. Uluslararası Teknoloji Transfer Konferansı
10 Ekim 2024

Lisans Öğrencilerine Yönelik TÜBİTAK 2209 Proje Hazırlama Eğitimi
10 Ekim 2024

TEKNOFEST ISIF24 Uluslararası Buluş Fuarı
08 Ekim 2024

GiriĹźimcilik EÄźitimi
08 Ekim 2024

TĂśBÄ°TAK BÄ°DEB 2237-A
07 Ekim 2024

TĂśBÄ°TAK 1001 Proje DesteÄźi
07 Ekim 2024

TĂśBÄ°TAK 1002 Proje DesteÄźi
07 Ekim 2024

TĂśBÄ°TAK 1001 Proje DesteÄźi
07 Ekim 2024

TĂśBÄ°TAK 1001 Proje DesteÄźi
07 Ekim 2024

TĂśBÄ°TAK 1001 Proje DesteÄźi
07 Ekim 2024

TÜBİTAK 2209 A/B Programları Bilgilendirme Etkinliği
07 Ekim 2024

Projesinin 2. Konsorsiyum Toplantısı İspanya'da Gerçekleştirildi
07 Ekim 2024

Ä°novasyon Ă–dĂĽlĂĽ!
03 Ekim 2024

Ăśniversite Sanayi Ä°Ĺź BirliÄźi Faaliyetleri
03 Ekim 2024

TĂśBÄ°TAK 1002 Proje DesteÄźi
03 Ekim 2024

COST Aksiyonuna Atanan Araştırmacımıza Tebrik
02 Ekim 2024

TĂśBÄ°TAK 3501 Proje DesteÄźi
02 Ekim 2024

Dr. Ă–Äźr. Ăśyesi Mehmet TURHAL ve Dr. Ă–Äźr. Ăśyesi Cenk ALBAYRAK'a TĂśBÄ°TAK 1501 Proje DesteÄźi
01 Ekim 2024

Prof. Dr. Kadir TĂśRK'e TĂśBÄ°TAK 1501 Proje DesteÄźi
01 Ekim 2024

Prof. Dr. Gençağa PÜRÇEK ve Dr. Öğr. Üyesi KÜRŞAT İÇİN'e TÜBİTAK 1501 Proje Desteği
01 Ekim 2024

Dr. Ă–Äźr. Ăśyesi Rukiye SAVRAN KIZILTEPE'ye TĂśBÄ°TAK 1507 Proje DesteÄźi
30 EylĂĽl 2024

Dr. Ă–Äźr. Ăśyesi Mustafa Bilgehan Ä°MAMOÄžLU'na TĂśBÄ°TAK 1501 Proje DesteÄźi
27 EylĂĽl 2024

Ăśniversite Sanayi Ä°Ĺź BirliÄźi Faaliyetleri
25 EylĂĽl 2024

TĂśBÄ°TAK 1002 Proje DesteÄźi
23 EylĂĽl 2024

TĂśBÄ°TAK 1002 Proje DesteÄźi
23 EylĂĽl 2024

Arş. Gör. Elif GÜN'e TÜBİTAK 1002 Proje Desteği
19 EylĂĽl 2024

Arş. Gör. Dr. Serhat SEVGİ'ye TÜBİTAK 1002 Proje Desteği
19 EylĂĽl 2024

2237-A TÜBİTAK 1505 Üniversite Sanayi İş Birliği Destek Programı Proje Hazırlama Eğitimi
13 EylĂĽl 2024

Erasmus+ KA2 Yükseköğretimde İş Birliği Ortaklıkları (KA220-HED) Proje Desteği
11 EylĂĽl 2024

TÜBİTAK 3005- Sosyal ve Beşeri Bilimlerde Yenilikçi Çözümler Araştırma Projeleri Destek Programı
06 EylĂĽl 2024

7 farklı kurumdan toplamda 24 araştırmacının katılımıyla KTÜ TTM ev sahipliğinde gerçekleştirilmiştir.
06 EylĂĽl 2024

2024 Ağustos Ayı Bülteni
04 EylĂĽl 2024

TÜBİTAK 1001 - Bilimsel ve Teknolojik Araştırma Projelerini Destekleme Programı
02 EylĂĽl 2024

TÜBİTAK 3501 - Kariyer Geliştirme Programı
02 EylĂĽl 2024

COST Aksiyonlarına Atanan Araştırmacılarımıza Tebrik
29 AÄźustos 2024

TĂśBÄ°TAK-BUSINESS FINLAND (Finlandiya) Ä°kili Ä°Ĺź BirliÄźi
27 AÄźustos 2024

Innovative Bio-Based Building Materials with Thermal Energy Storage Function (MYCOBUILD)
23 AÄźustos 2024

Strengthening Technology Transfer Ecosystem through Innovative and Digital Approaches- STEIDA
22 AÄźustos 2024

T3N-BSB Transnational Technology Transfer Network for the Black Sea Basin
15 AÄźustos 2024

Tanışma Toplantısı
12 AÄźustos 2024

2024 Temmuz Ayı Bülteni
01 AÄźustos 2024

COST Aksiyonlarına Atanan Araştırmacılarımıza Tebrik
01 AÄźustos 2024

TĂśBÄ°TAK 1002 Proje DesteÄźi
31 Temmuz 2024

Kapanış Töreni
30 Temmuz 2024

TĂśBÄ°TAK 1002 Proje DesteÄźi
24 Temmuz 2024

Üniversite Tercih Rehberi Yayınlandı
24 Temmuz 2024

YĂ–KAK Ara DeÄźerlendirme
19 Temmuz 2024

TĂśBÄ°TAK 1001 Proje DesteÄźi
17 Temmuz 2024

TÜBİTAK 2244 Sanayi Doktora Programı
17 Temmuz 2024

''Development of Wood Science Master Programme (Wood-Mas)''
12 Temmuz 2024

Son BaĹźvuru Tarihi: 9 AÄźustos 2024
11 Temmuz 2024

TĂśBÄ°TAK 1002 Proje DesteÄźi
09 Temmuz 2024

TĂśBÄ°TAK 1002 Proje DesteÄźi
08 Temmuz 2024

Ulusal Fon Kaynaklı Destek Programları Bilgilendirme Etkinliği
02 Temmuz 2024

2024 Haziran Ayı Bülteni
01 Temmuz 2024

TÜBİTAK BİDEB 2218, 2219, 2224 Programları Bilgilendirme Etkinliği
26 Haziran 2024

Ăśniversite Sanayi Ä°Ĺź BirliÄźi Faaliyetleri
26 Haziran 2024

TÜBİTAK 1002 - Hızlı Destek Programı
24 Haziran 2024

TÜBİTAK 1002 - Hızlı Destek Programı
24 Haziran 2024

TÜBİTAK 3005 - Sosyal Ve Beşeri Bilimlerde Yenilikçi Çözümler Araştırma Projeleri Destekleme Programı
24 Haziran 2024

TÜSEB A Grubu Acil Ar-Ge Proje Çağrısı Programı
24 Haziran 2024

Ăśniversite Sanayi Ä°ĹźbirliÄźi Faaliyetleri
07 Haziran 2024

Patent,Faydalı Model ve Tasarım Tescil Tebrik Töreni
07 Haziran 2024

TĂśBÄ°TAK 2237/B Proje DesteÄźi
05 Haziran 2024

TĂśBÄ°TAK 2237/B Proje DesteÄźi
05 Haziran 2024

TĂśBÄ°TAK 2237/A Proje DesteÄźi
05 Haziran 2024

TĂśBÄ°TAK 2237/A Proje DesteÄźi
05 Haziran 2024

TĂśBÄ°TAK 2237/A Proje DesteÄźi
05 Haziran 2024

TĂśBÄ°TAK 2237/A Proje DesteÄźi
05 Haziran 2024

TĂśBÄ°TAK 2237/A Proje DesteÄźi
05 Haziran 2024

TĂśBÄ°TAK 2237/A Proje DesteÄźi
05 Haziran 2024

TĂśBÄ°TAK 2237/A Proje DesteÄźi
05 Haziran 2024

TĂśBÄ°TAK 2237/A Proje DesteÄźi
05 Haziran 2024

TĂśBÄ°TAK 2237/A Proje DesteÄźi
05 Haziran 2024

TĂśBÄ°TAK 2237/A Proje DesteÄźi
05 Haziran 2024

TĂśBÄ°TAK 2237/A Proje DesteÄźi
05 Haziran 2024

TĂśBÄ°TAK 2237/A Proje DesteÄźi
05 Haziran 2024

TĂśBÄ°TAK 3501 Proje DesteÄźi
05 Haziran 2024

COST Aksiyonlarına Atanan Araştırmacılarımıza Tebrik
04 Haziran 2024

Kamu Destekli Proje
04 Haziran 2024

BİDEB 2237 Programları
04 Haziran 2024

2024 Mayıs Ayı Bülteni
04 Haziran 2024

Faydalı Model Başvurusu
30 Mayıs 2024

TĂśBÄ°TAK 1002 Proje DesteÄźi
28 Mayıs 2024

COST Programı
24 Mayıs 2024

TÜBİTAK Burs Programları Bilgilendirme Etkinliği
23 Mayıs 2024

Ekosistem Ziyaretleri
22 Mayıs 2024

Patentle Türkiye - Üniversiteler Patent Yarışması
22 Mayıs 2024

TĂśSEB Proje DesteÄźi
20 Mayıs 2024

TÜBİTAK 3005 - Sosyal ve Beşeri Bilimlerde Yenilikçi Çözümler Araştırma Projeleri Destek Programı
17 Mayıs 2024

Ön Hızlandırıcı Programı
17 Mayıs 2024

Ăśniversite ve Sanayi Ä°ĹźbirliÄźi
15 Mayıs 2024

TÜBİTAK 1812 Yatırım Tabanlı Girişimcilik Destek Programı
15 Mayıs 2024

TĂśBÄ°TAK 1002 Proje DesteÄźi
14 Mayıs 2024

TĂśBÄ°TAK 1002 Proje DesteÄźi
14 Mayıs 2024

TĂśBÄ°TAK 1002 Proje DesteÄźi
14 Mayıs 2024

Faydalı Model Başvurusu
13 Mayıs 2024

Faydalı Model Başvurusu
13 Mayıs 2024

Ulusal Patent BaĹźvurusu
13 Mayıs 2024

Ulusal Patent BaĹźvurusu
13 Mayıs 2024

TÜBİTAK 2244 Sanayi Doktora Programı
10 Mayıs 2024

Ondokuz Mayıs Üniversitesi ev sahipliğinde gerçekleştirilmiştir.
09 Mayıs 2024

TÜSEB-A Grubu Acil Ar-Ge Programı
07 Mayıs 2024

TÜSEB-A Grubu Acil Ar-Ge Programı
07 Mayıs 2024

TÜSEB-A Grubu Acil Ar-Ge Programı
07 Mayıs 2024

TĂĽrkiye'nin Patent Raporu 2023
03 Mayıs 2024

Girişimcilik ve TÜBİTAK Destek Programları Bilgilendirme Etkinliği
03 Mayıs 2024

Ön Lisans Öğrencilerine TÜBİTAK Burs Programları Bilgilendirme Etkinliği
03 Mayıs 2024

Destek Programları Bilgilendirme Etkinliği
30 Nisan 2024

Bilgilendirme EtkinliÄźi
29 Nisan 2024

TÜBİTAK 1001 ''Cumhuriyetimizin 100. Yılı Özel Çağrısı'' Proje Desteği
25 Nisan 2024

TÜBİTAK 1001 ''Cumhuriyetimizin 100. Yılı Özel Çağrısı'' Proje Desteği
25 Nisan 2024

Cumhuriyetimizin 100. Yılı Özel Çağrısı
25 Nisan 2024

Ulusal Patent BaĹźvurusu
22 Nisan 2024

COST Aksiyonu Tebrik
15 Nisan 2024

TĂśBÄ°TAK 1002 Proje DesteÄźi
05 Nisan 2024

2024 Mart Ayı Bülteni
03 Nisan 2024

TĂśBÄ°TAK 1002 Proje DesteÄźi
02 Nisan 2024

TĂśBÄ°TAK 1002 Proje DesteÄźi
27 Mart 2024

TÜBİTAK 3501 - Kariyer Geliştirme Programı
26 Mart 2024

TÜBİTAK 2209-A Programı 124 Kabul, TÜBİTAK 2209-B Programı 19 Kabul
22 Mart 2024

TĂśBÄ°TAK 1002 Proje DesteÄźi
20 Mart 2024

TĂśBÄ°TAK 1002 Proje DesteÄźi
20 Mart 2024

TĂśSEB Proje DesteÄźi
20 Mart 2024

Üniversite Öğrencilerine Yönelik TÜBİTAK Burs Programları
18 Mart 2024

Bilgilendirme EtkinliÄźi
15 Mart 2024

Ulusal Patent BaĹźvurusu
15 Mart 2024

Tasarım Başvurusu
14 Mart 2024

Tasarım Başvurusu
14 Mart 2024

Tasarım Başvurusu
14 Mart 2024

Ulusal Patent BaĹźvurusu
14 Mart 2024

Uluslararası Patent Başvurusu
14 Mart 2024

Strengthening Technology Transfer Ecosystem through Innovative and Digital Approaches
06 Mart 2024

Ăśniversite Sanayi Ä°Ĺź BirliÄźi Faaliyetleri
06 Mart 2024

2024 Şubat Ayı Bülteni
05 Mart 2024

Ăśniversite Sanayi Ä°Ĺź BirliÄźi Faaliyetleri
29 Ĺžubat 2024

Erasmus+ KA154-YOU Gençlik Katılımı Programı Proje Desteği
28 Ĺžubat 2024

TÜBİTAK 2237-A Programı
28 Ĺžubat 2024

M-ERA.NET Proje DesteÄźi
27 Ĺžubat 2024

COST Programına Çalışma Grubu Üyesi (WG)
26 Ĺžubat 2024

TĂśBÄ°TAK 1001 Proje DesteÄźi
26 Ĺžubat 2024

TĂśBÄ°TAK 1001 Proje DesteÄźi
26 Ĺžubat 2024

TĂśBÄ°TAK 1001 Proje DesteÄźi
26 Ĺžubat 2024

2023/2. Dönem kapsamında üniversitemizden bir sonraki dönemi beklemeden başvuru imkanı sağlanan 3 projeden tümü desteklenmeye hak kazanmıştır.
26 Ĺžubat 2024

TÜBİTAK BİDEB 2244 Sanayi Doktora Programı Kapsamında Bursiyer Görüşmeleri
20 Ĺžubat 2024

TĂśBÄ°TAK Kutup 1001 Proje DesteÄźi
19 Ĺžubat 2024

COST Programına Yönetim Komitesi Üyesi (MC) ve Çalışma Grubu Üyesi (WG)
19 Ĺžubat 2024

COST Programı Bilgilendirme Etkinliği
12 Ĺžubat 2024

Interreg NEXT Karadeniz Havzasında Sınır Ötesi İş Birliği Programı Kapsamında Proje Desteği
09 Ĺžubat 2024

Interreg NEXT Karadeniz Havzasında Sınır Ötesi İş Birliği Programı Kapsamında Proje Desteği
09 Ĺžubat 2024

Interreg NEXT Karadeniz Havzasında Sınır Ötesi İş Birliği Programı Kapsamında Proje Desteği
09 Ĺžubat 2024

Interreg NEXT Karadeniz Havzasında Sınır Ötesi İş Birliği Programı Kapsamında Proje Desteği
09 Ĺžubat 2024

COST Programına Çalışma Grubu Üyesi (WG)
07 Ĺžubat 2024

COST Programına Çalışma Grubu Üyesi (WG)
07 Ĺžubat 2024

TÜBİTAK 3005 Destek Programı Bilgilendirme Etkinliği
07 Ĺžubat 2024

TÜBİTAK 2232 A-B Programları Bilgilendirme Etkinliği
07 Ĺžubat 2024

2024 Ocak Ayı Bülteni
05 Ĺžubat 2024

Karadeniz Havzasında Sınır Ötesi İş Birliği Programı
05 Ĺžubat 2024

TĂśBÄ°TAK 3501 Proje DesteÄźi
31 Ocak 2024

TĂśBÄ°TAK 3501 Proje DesteÄźi
31 Ocak 2024

TĂśBÄ°TAK 2237/A Proje DesteÄźi
29 Ocak 2024

Ăśniversite Sanayi Ä°Ĺź BirliÄźi Faaliyetleri
29 Ocak 2024

Son BaĹźvuru Tarihi: 11.02.2024
29 Ocak 2024

Erasmus+ Programı Mentörlük Günleri Etkinliği
25 Ocak 2024

Proje Fikri Geliştirme ve Proje Hazırlama Eğitimi
25 Ocak 2024

Yüksek Miktarda Biyofilm Oluşturan Bazı Mantarlardan Ekolojik, Ekonomik ve Sürdürülebilir Ahşap Yüzey Kaplama Malzemesinin Geliştirilmesi
25 Ocak 2024

Vajinal Doğum Yapan Annelere Motivasyonel Görüşme Tekniği ile Verilen Emzirme Eğitiminin Emzirme Motivasyonu, Özyeterliliği ve Bağlanma Üzerine Etkisi
25 Ocak 2024

CA22127 - COllaboratively DEveloped culturallY Appropriate and inclusive Assessment tool for Palliative Care EDUcation (CODE-YAA@PC-EDU)
25 Ocak 2024

Erasmus+ Programı 2024
19 Ocak 2024

TĂśBÄ°TAK 2237/A Proje DesteÄźi
17 Ocak 2024

TĂśBÄ°TAK 2237/A Proje DesteÄźi
17 Ocak 2024

ĂśBÄ°TAK 2237/A Proje DesteÄźi
17 Ocak 2024

TĂśBÄ°TAK 2237/A Proje DesteÄźi
17 Ocak 2024

TĂśBÄ°TAK 2237/A Proje DesteÄźi
17 Ocak 2024

TĂśBÄ°TAK 2237/A Proje DesteÄźi
17 Ocak 2024

TĂśBÄ°TAK 2237/A Proje DesteÄźi
17 Ocak 2024

COST Programına Çalışma Grubu Üyesi (WG)
17 Ocak 2024

TĂśBÄ°TAK 1002 Proje DesteÄźi
16 Ocak 2024

KTĂś TTM'ye Ziyaret
16 Ocak 2024

Dicle Üniversitesi ev sahipliğinde gerçekleştirilmiştir.
11 Ocak 2024

TĂśBÄ°TAK-COST 2515 Proje DesteÄźi
11 Ocak 2024

Uluslararası Proje Yazma Eğitimi
10 Ocak 2024

Ăśniversite-Sanayi Ä°Ĺź BirliÄźi
10 Ocak 2024

DOKAFÂ’24
09 Ocak 2024

2023 Aralık Ayı Bülteni
05 Ocak 2024

TÜBİTAK BiGG Programı
03 Ocak 2024

TÜBİTAK BiGG Programı
03 Ocak 2024

TÜBİTAK BiGG Programı
03 Ocak 2024

TÜBİTAK BiGG Programı
03 Ocak 2024

TÜBİTAK BiGG Programı
03 Ocak 2024

TÜBİTAK BiGG Programı
03 Ocak 2024

TĂśBÄ°TAK 1001 Proje DesteÄźi
02 Ocak 2024

TĂśBÄ°TAK 1001 Proje DesteÄźi
02 Ocak 2024

TĂśBÄ°TAK 1001 Proje DesteÄźi
02 Ocak 2024

TĂśBÄ°TAK 1001 Proje DesteÄźi
02 Ocak 2024

TĂśBÄ°TAK 1001 Proje DesteÄźi
02 Ocak 2024

TÜBİTAK 1001 Programı 2023/2. Dönem
02 Ocak 2024

TÜBİTAK 3501 - Kariyer Geliştirme Programı
28 Aralık 2023

Farklı İklim Projeksiyonları Kullanılarak Gelecekteki Asli Orman Ağacı Türlerinin Dağılımlarının Tahmin Edilmesi ve Türkiye İçin Uyum Stratejilerinin Geliştirilmesi
28 Aralık 2023

2023 Yılı Dış Paydaş ve İç Paydaş Toplantıları
27 Aralık 2023

TĂśBÄ°TAK 3501 Proje DesteÄźi
27 Aralık 2023

Ufuk Avrupa Programı ve Uluslararası Konsorsiyumlara Dahil Olma
26 Aralık 2023

TĂśBÄ°TAK 1002 Proje DesteÄźi
26 Aralık 2023

2023 Yılı Bilgi ve Doküman Birimleri İstişare Toplantısı
26 Aralık 2023

CA22114 - Maternal Perinatal Stress and Adverse Outcomes in the Offspring: Maximising infants´development (TREASURE)
20 Aralık 2023

CA22170 - TEndon Regeneration NETwork (TENET)
20 Aralık 2023

Empowering Women in Becoming the Agents of Change to Close the Digital Skills Gap in the Labour Market
19 Aralık 2023

Destek almaya hak kazanan 6 girişimcimizi tebrik eder başarılarının devamını dileriz.
18 Aralık 2023

CA22137 - Randomised Optimisation Algorithms Research Network (ROAR-NET)
18 Aralık 2023

CA22159 - National, International and Transnational Histories of Healthcare, 1850-2000 (EuroHealthHist)
18 Aralık 2023

CA22137 - Randomised Optimisation Algorithms Research Network (ROAR-NET)
18 Aralık 2023

Fikri ve Sınai Mülkiyet Hakları ve COST Programı Bilgilendirme Etkinliği
15 Aralık 2023

CA22164 - european Network on Extreme fiRe behaviOr (NERO)
13 Aralık 2023

CA22164 - european Network on Extreme fiRe behaviOr (NERO)
11 Aralık 2023

Erasmus+ Yükseköğretim Alanı Merkezi Projeler Bilgilendirme Toplantısı
08 Aralık 2023

TĂśBÄ°TAK ARDEB 3005 EtkinliÄźi
08 Aralık 2023

Avrupa Birliği Çerçeve Programları Bilgilendirme Etkinliği
05 Aralık 2023

2023 Kasım Ayı Bülteni
05 Aralık 2023

Erasmus+ EÄźitimi
01 Aralık 2023

TĂśBÄ°TAK TEYDEB 1501 Projesi TicarileĹźme
30 Kasım 2023

COST Programına Çalışma Grubu Üyesi (WG)
29 Kasım 2023

Girişimcilik Konulu Deneyim Paylaşımı
29 Kasım 2023

Proje Hazirlama EÄźitimi
27 Kasım 2023

GiriĹźimcilik EÄźitimi
27 Kasım 2023

COST Programına Çalışma Grubu Üyesi (WG)
27 Kasım 2023

LegalTech Breakthrough Awards’da 2023 yılı Overall Legal Analytics Innovation of the Year
24 Kasım 2023

Düşünden Gerçeğine Proje Pazarı
24 Kasım 2023

Ä°Ĺź BirliÄźi Ziyareti
15 Kasım 2023

TĂśBÄ°TAK 2209 A ve 2209 B Projeleri
15 Kasım 2023

"NEETs are Accessing to Market'' Projesinin Koordinasyon Toplantısı
14 Kasım 2023

Ăśniversite Sanayi Ä°Ĺź BirliÄźi
13 Kasım 2023

Ăśniversite Sanayi Ä°Ĺź BirliÄźine
13 Kasım 2023

Ăśniversite-Sanayi Ä°Ĺź BirliÄźi
10 Kasım 2023

COST Programına Çalışma Grubu Üyesi (WG)
09 Kasım 2023

COST Programına Çalışma Grubu Üyesi (WG)
09 Kasım 2023

COST Programına Çalışma Grubu Üyesi (WG)
09 Kasım 2023

COST Programına Çalışma Grubu Üyesi (WG)
09 Kasım 2023

TĂśBÄ°TAK-COST 2515 Proje DesteÄźi
09 Kasım 2023

2023 Ekim Ayı Bülteni
07 Kasım 2023

Yalın Üretim Sistemi
06 Kasım 2023

Proje Açılışı Toplantısı
02 Kasım 2023

Ăśniversite Sanayi Ä°Ĺź BirliÄźi
02 Kasım 2023

Erasmus+ KA2 Yükseköğretimde İş Birliği Ortaklıkları (KA220-HED) Proje Desteği
01 Kasım 2023

Teknik Ziyaret Gerçekleştirdi
01 Kasım 2023

TÜBİTAK Burs Programları Bilgilendirme Semineri
26 Ekim 2023

Lisans Öğrencilerine Yönelik Bilgilendirme Semineri
25 Ekim 2023

GiriĹźimcilik EÄźitimi
24 Ekim 2023

Karadeniz Bölgesine Bir Ar-Ge Merkezi
23 Ekim 2023

Ulusal Patent BaĹźvurusu
20 Ekim 2023

Ulusal Patent BaĹźvurusu
20 Ekim 2023

Ulusal Patent BaĹźvurusu
20 Ekim 2023

Ulusal Patent BaĹźvurusu
19 Ekim 2023

Ulusal Patent BaĹźvurusu
19 Ekim 2023

Ulusal Patent BaĹźvurusu
19 Ekim 2023

5. Savunma Sanayii Buluşmaları Etkinliği
19 Ekim 2023

Ăśniversite Sanayi Ä°Ĺź BirliÄźi Faaliyetleri
19 Ekim 2023

TÜBİTAK 2237-A Programı
18 Ekim 2023

COST Programına Çalışma Grubu Üyesi (WG)
12 Ekim 2023

Ăśniversite Sanayi Ä°Ĺź BirliÄźi
06 Ekim 2023

2023 Düşünden Gerçeğine Proje Pazarı
06 Ekim 2023

TĂśBÄ°TAK 2237/A Proje DesteÄźi
06 Ekim 2023

COST Programına Çalışma Grubu Üyesi (WG)
06 Ekim 2023

COST Programına Çalışma Grubu Üyesi (WG)
06 Ekim 2023

COST Programına Çalışma Grubu Üyesi (WG)
06 Ekim 2023

COST Programına Çalışma Grubu Üyesi (WG)
05 Ekim 2023

BİDEB 2237 Programı
04 Ekim 2023

2023 Eylül Ayı Bülteni
04 Ekim 2023

TÜBİTAK 2209 Programları 2023/1. Dönem Sonuçları
03 Ekim 2023

TĂśBÄ°TAK-COST 2515 Proje DesteÄźi
26 EylĂĽl 2023

KTÜ TTM, dijital varlık yönetimi ve blockchain teknolojilerinde öncü olan Blockville Digital Assets firması ile çevrim içi bir tanışma toplantısı düzenledi.
22 EylĂĽl 2023

Doğu Karadeniz Kalkınma Ajansı (DOKA) Genel Sekreterliği görevine atanan Kemal Akpınar, KTÜ TTM Tarafından ziyaret edildi.
22 EylĂĽl 2023

Girişimciler Türkiye Girişimci Buluşması
20 EylĂĽl 2023

Trabzon Ticaret Borsası (TTB) ve Karadeniz Teknik Üniversitesi (KTÜ) ortaklığı
19 EylĂĽl 2023

TÜBİTAK 1001 Programı
19 EylĂĽl 2023

Gelecek Vadeden Girişimler 24 Yarışması Başlıyor
06 EylĂĽl 2023

Erasmus+ KA2 Yükseköğretimde İş Birliği Ortaklıkları (KA220-HED) Proje Desteği
05 EylĂĽl 2023

TÜBİTAK 1002-A Hızlı Destek Modülü
01 EylĂĽl 2023

2023 Ağustos Ayı Bülteni
01 EylĂĽl 2023

TÜBİTAK Teknoloji ve Yenilik Destek Programları Başkanlığı (TEYDEB) kapsamında yürütülmekte olan destek programlarının bütçeleri güncellenmiştir.
01 EylĂĽl 2023

TÜBİTAK 2244 Sanayi Doktora Programı Bursiyer Başvuru İlanı
31 AÄźustos 2023

Kontratlı Ar-Ge Projesi
31 AÄźustos 2023

CA21130 - P2x Receptors as a Therapeutic Opportunity (PRESTO)
29 AÄźustos 2023

TĂśBÄ°TAK 1002-B Acil Destek ModĂĽlĂĽ
18 AÄźustos 2023

Bütçe Güncellemesi
15 AÄźustos 2023

Bu sürece katkı sağladıkları için KTÜ'lü Araştırmacılarımıza teşekkür ederiz.
14 AÄźustos 2023

TÜBİTAK 1002-A Hızlı Destek Modülü
14 AÄźustos 2023

TĂśBÄ°TAK 1002-B Acil Destek ModĂĽlĂĽ
14 AÄźustos 2023

2023 Temmuz Ayı Bülteni
08 AÄźustos 2023

2023 YKS Tercih Dönemi
04 AÄźustos 2023

Avrupa BirliÄźi Projesi
04 AÄźustos 2023

TĂśBÄ°TAK Proje DesteÄźi
04 AÄźustos 2023

LIFT UP++ Sanayi Odaklı Doktora Araştırmaları Programı
02 AÄźustos 2023

TĂśBÄ°TAK 3501 Proje DesteÄźi
01 AÄźustos 2023

TÜBİTAK 1001 Programı
31 Temmuz 2023

Avrupa BirliÄźi Projesi
25 Temmuz 2023

ĂśNÄ°VERSÄ°TE TERCÄ°H REHBERÄ°
24 Temmuz 2023

TĂśBÄ°TAK 1505 Proje DesteÄźi!
24 Temmuz 2023

COST Programına Çalışma Grubu Üyesi (WG)
21 Temmuz 2023

COST Programına Çalışma Grubu Üyesi (WG)
20 Temmuz 2023

TĂśBÄ°TAK 2237/A Proje DesteÄźi
19 Temmuz 2023

COST Programına Çalışma Grubu Üyesi (WG)
19 Temmuz 2023

COST Programına Çalışma Grubu Üyesi (WG)
18 Temmuz 2023

Ăśniversite Sanayi Ä°ĹźbirliÄźi Faaliyetleri
17 Temmuz 2023

Horizon Europe Proje DesteÄźi
17 Temmuz 2023

Ăśniversite Sanayi Ä°Ĺź BirliÄźi Faaliyetleri
14 Temmuz 2023

COST Programına Çalışma Grubu Üyesi (WG)
14 Temmuz 2023

“CA21144 - Superconducting Nanodevices and Quantum Materials for Coherent Manipulation (SUPERQUMAP)” aksiyonuna Çalışma Grubu Üyesi (WG) olarak atanmıştır.
13 Temmuz 2023

Proje Hazırlama Eğitimi
12 Temmuz 2023

Ăśniversite Sanayi Ä°Ĺź BirliÄźi
11 Temmuz 2023

BİDEB 2244-Sanayi Doktora Programı
10 Temmuz 2023

TÜBİTAK TEYDEB Destek Programları Bilgilendirme Etkinliği
07 Temmuz 2023

COST Programına Çalışma Grubu Üyesi (WG)
07 Temmuz 2023

2023 Haziran Ayı Bülteni
07 Temmuz 2023

COST Programına Çalışma Grubu Üyesi (WG)
07 Temmuz 2023

TĂśBÄ°TAK Proje DesteÄźi
07 Temmuz 2023

Proje adı: 3 Boyutlu Eklemeli İmalat Yöntemleri Uygulamalı Eğitimi
06 Temmuz 2023

Proje adı: Kahramanmaraş Depremi Sonrası Yeniden Hayata Dönüş: Gönüllü Öğretmenler için Travmaya Duyarlı Eğitim
06 Temmuz 2023

Proje adı: Akademik Düzeyde Bilimsel Araştırma Projesi Hazırlama Eğitimi
06 Temmuz 2023

Proje adı: Lisans Öğrencilerinin Bilimsel Araştırma Projesi Hazırlama Kapasitesinin Artırılması
06 Temmuz 2023

Ăśniversite Sanayi Ä°Ĺź BirliÄźi Faaliyetleri
04 Temmuz 2023

Trabzon Kadın Girişimciler Kurulu Temmuz Ayı Yönetim Kurulu Toplantısı
04 Temmuz 2023

TĂśBÄ°TAK ARDEB Bilgilendirme EtkinliÄźi
04 Temmuz 2023

Öğr. Gör. İslam YILDIZ tarafından Üniversitemiz araştırmacılarına yönelik, KTÜ TTM Seminer Salonu’nda gerçekleştirildi.
14 Haziran 2023

TĂśBÄ°TAK Proje DesteÄźi
09 Haziran 2023

TĂśBÄ°TAK KUTUP-1001 Proje DesteÄźi
08 Haziran 2023

TÜSEB Programları Bilgilendirme Etkinliği
08 Haziran 2023

Erasmus+ KA2 Programları Bilgilendirme Etkinliği
08 Haziran 2023

COST Programına Çalışma Grubu Üyesi (WG)
08 Haziran 2023

COST Programına Çalışma Grubu Üyesi (WG)
08 Haziran 2023

ARGEMİP Ar-Ge ve Tasarım Merkezleri İletişim ve İş Birliği Platformu İle Tanışma Toplantısı
08 Haziran 2023

2023 Mayıs Ayı Bülteni
02 Haziran 2023

Üniversite Sanayi İş Birliği Programları Bilgilendirme Etkinliği
01 Haziran 2023

Ăśniversite Sanayi Ä°Ĺź BirliÄźi
31 Mayıs 2023

COST Programına Çalışma Grubu Üyesi (WG)
31 Mayıs 2023

Bilgilendirme EtkinliÄźi
26 Mayıs 2023

İş Birliği Toplantısı
26 Mayıs 2023

Patent Raporu Yayınlandı !
24 Mayıs 2023

COST Programı Bilgilendirme Etkinliği
23 Mayıs 2023

DOKA Teknik Destek Programı Kapsamında Firma Ziyareti
23 Mayıs 2023

Lisans ve Önlisans Öğrencilerine Yönelik TÜBİTAK 2209 A/B Programları Bilgilendirme Etkinliği
22 Mayıs 2023

TTSO'dan KTĂś TTM'ye Ziyaret
18 Mayıs 2023

Ăśniversite Sanayi Ä°Ĺź birliÄźi Faaliyetleri
18 Mayıs 2023

COST Aksiyonu
18 Mayıs 2023

TĂśBÄ°TAK Proje DesteÄźi
18 Mayıs 2023

Etkinlik 11 farklı kurumdan toplamda 24 araştırmacının katılımıyla KTÜ TTM ev sahipliğinde gerçekleştirilmiştir.
17 Mayıs 2023

Firma Ziyareti
17 Mayıs 2023

TĂśBÄ°TAK Proje DesteÄźi
17 Mayıs 2023

TĂśBÄ°TAK Proje DesteÄźi
17 Mayıs 2023

Ăśniversite Sanayi Ä°ĹźbirliÄźi Faaliyetleri
16 Mayıs 2023

Uygulamalı Eğitim
12 Mayıs 2023

2023 Nisan Ayı Bülteni
11 Mayıs 2023

Firma Ziyareti
11 Mayıs 2023

COST Programına Çalışma Grubu Üyesi (WG)
10 Mayıs 2023

TĂśBÄ°TAK Proje DesteÄźi
10 Mayıs 2023

Ä°stanbul ISIF'23
03 Mayıs 2023

COST Aksiyon Başarıları
28 Nisan 2023

Ăśniversite-Sanayi Ä°Ĺź BirliÄźi
26 Nisan 2023

TÜBİTAK 2209 A/B Programları Çevrimiçi Bilgilendirme Etkinliği
19 Nisan 2023

TĂśBÄ°TAK Proje DesteÄźi
19 Nisan 2023

Ăśniversite-Sanayi Ä°Ĺź BirliÄźi
18 Nisan 2023

Ăśniversite-Sanayi Ä°ĹźbirliÄźi
18 Nisan 2023

COST Programına Çalışma Grubu Üyesi (WG)
17 Nisan 2023

Kariyer Geliştirme Programı Bilgilendirme Etkinliği
17 Nisan 2023

TÜBİTAK 2244-Sanayi Doktora Programı
14 Nisan 2023

TĂśBÄ°TAK Proje DesteÄźi
14 Nisan 2023

TÜBİTAK 1512 BİGG Programı
12 Nisan 2023

TĂśSEB Proje DesteÄźi
12 Nisan 2023

COST Programına Çalışma Grubu Üyesi (WG)
11 Nisan 2023

Üniversite-Sanayi İş Birliğine Katkısı
10 Nisan 2023

Sınai Mülkiyet Hakları Eğitimi Verildi
10 Nisan 2023

NATO - Science for Peace and Security Programı Kapsamında Proje Desteği
10 Nisan 2023

COST Programına Çalışma Grubu Üyesi (WG)
07 Nisan 2023

TÜSİAD Bu Gençlikte İŞ Var!
06 Nisan 2023

EĹźik ĂśstĂĽ Ă–dĂĽl
06 Nisan 2023

2023 Mart Ayı Bülteni
06 Nisan 2023

2022 Yılı Girişimci ve Yenilikçi Üniversite Endeksi
05 Nisan 2023

Verimlilik 2023 Proje Ă–dĂĽlleri
05 Nisan 2023

13. RoboBoat 2023 Elektrikli Otonom Su Üstü Araç Yarışması
05 Nisan 2023

TĂśBÄ°TAK 3005 Proje DesteÄźi
04 Nisan 2023

Firma-Akademisyen Ä°Ĺźbirlikleri
03 Nisan 2023

TĂśBÄ°TAK 3501 Proje DesteÄźi
31 Mart 2023

COST Programına Çalışma Grubu Üyesi (WG)
31 Mart 2023

TĂśBÄ°TAK 2232-A
31 Mart 2023

TĂśSEB Proje DesteÄźi
30 Mart 2023

Ulusal Patent BaĹźvurusu
30 Mart 2023

Ulusal Faydalı Model Başvurusu
29 Mart 2023

TĂśBÄ°TAK-TAGEM Proje DesteÄźi
29 Mart 2023

COST Programına Çalışma Grubu Üyesi (WG)
29 Mart 2023

Ulusal Patent BaĹźvurusu
28 Mart 2023

TĂśBÄ°TAK-TAGEM Proje DesteÄźi
28 Mart 2023

COST Programına Çalışma Grubu Üyesi (WG)
28 Mart 2023

TÜBİTAK 2244 Sanayi Doktora Programı
24 Mart 2023

TÜBİTAK 2209/A ve 2209/B Programları
21 Mart 2023

KTÜ TTM ve TÜBİTAK Uluslararası İşbirliği Daire Başkanlığı'nın organizasyonuyla 15 Mart 2023 tarihinde gerçekleştirildi.
16 Mart 2023

Ăśniversite-Sanayi Ä°Ĺź BirliÄźi
10 Mart 2023

TÜBİTAK BİDEB 2244-Sanayi Doktora Programı
09 Mart 2023

Ăśniversite-Sanayi Ä°Ĺź BirliÄźi
09 Mart 2023

Ăśniversite Sanayi Ä°Ĺź BirliÄźi
08 Mart 2023

2023 Şubat Ayı Bülteni
06 Mart 2023

COST Programına Çalışma Grubu Üyesi (WG)
28 Ĺžubat 2023

TĂśBÄ°TAK Proje DesteÄźi
27 Ĺžubat 2023

COST Programına Çalışma Grubu Üyesi (WG)
27 Ĺžubat 2023

COST Programına Çalışma Grubu Üyesi (WG)
24 Ĺžubat 2023

COST Programına Çalışma Grubu Üyesi (WG)
23 Ĺžubat 2023

COST Programına Çalışma Grubu Üyesi (WG)
22 Ĺžubat 2023

COST Programına Çalışma Grubu Üyesi (WG)
22 Ĺžubat 2023

COST Programına Çalışma Grubu Üyesi (WG)
21 Ĺžubat 2023

COST Programına Çalışma Grubu Üyesi (WG)
21 Ĺžubat 2023

Ăśniversite Sanayi Ä°ĹźbirliÄźi Faaliyetleri
21 Ĺžubat 2023

Trabzon firmalarından opuqo ile Bilgisayar Mühendisliği Bölümü öğretim üyelerinden Dr. Öğr. Üyesi Beste ÜSTİBİOĞLU ve Doç. Dr. Güzin ULUTAŞ ile proje hazırlıkları ile ilgili toplantı yapılmıştır.
20 Ĺžubat 2023

TĂśBÄ°TAK Proje DesteÄźi
15 Ĺžubat 2023

''CA18218 - European Burden of Disease Network'' aksiyonuna Çalışma Grubu Üyesi (WG) olarak atanmıştır.
03 Ĺžubat 2023

''CA21148 - Research And International Networking on Emerging Inorganic Chalcogenides for Photovoltaics (RENEW-PV)'' aksiyonuna Çalışma Grubu Üyesi (WG) olarak atanmıştır.
03 Ĺžubat 2023

COST Programına Çalışma Grubu Üyesi (WG)
02 Ĺžubat 2023

Firma Ziyareti
02 Ĺžubat 2023

COST Programına Çalışma Grubu Üyesi (WG)
02 Ĺžubat 2023

COST Programına Çalışma Grubu Üyesi (WG)
01 Ĺžubat 2023

COST Programına Çalışma Grubu Üyesi (WG)
01 Ĺžubat 2023

Firma Görüşmeleri
30 Ocak 2023

TĂśBÄ°TAK 2519 Proje DesteÄźi
30 Ocak 2023

TĂśBÄ°TAK 1512 BÄ°GG Proje DesteÄźi
27 Ocak 2023

BÄ°GGiriĹźim Konsorsiyumu
27 Ocak 2023

TĂśBÄ°TAK Proje DesteÄźi
26 Ocak 2023

COST Programına Çalışma Grubu Üyesi (WG)
25 Ocak 2023

TĂśBÄ°TAK 2535
24 Ocak 2023

COST Programına Çalışma Grubu Üyesi (WG)
24 Ocak 2023

''CA21162 - Establishing a Pan-European Network on Computational Redesign of Enzymes (COZYME) aksiyonuna Çalışma Grubu Üyesi (WG)'' olarak atanmıştır.
20 Ocak 2023

''CA21155 - Advanced Composites Under High Strain Rates Loading: A Route to Certification-By-Analysis (HISTRATE) aksiyonuna Çalışma Grubu Üyesi (WG)'' olarak atanmıştır.
20 Ocak 2023

Projesi ''TÜBİTAK 1002-A Hızlı Destek Modülü'' kapsamında desteklenmiştir.
20 Ocak 2023

''Toplam Üretken Bakım Yöntemlerini Uygulayarak Kaynak Verimliliğini Artırma Danışmanlığı'' başlıklı proje kapsamında Azelift Asansör San. ve Tic. A.Ş.’ye ziyaret gerçekleştirildi.
19 Ocak 2023

''CA21153 - Network For Implementing Multiomics Approaches in Atherosclerotic Cardiovascular Disease Prevention and Research (AtheroNet) aksiyonuna Çalışma Grubu Üyesi (WG)'' olarak atanmıştır.
18 Ocak 2023

Dr. Melek KOÇ KEŞİR, Üniversitemizde doktora sonrası araştırmalarına devam etmektedir.
18 Ocak 2023

Ziyarette, 2023 yılı için üniversite sanayi iş birliğinde izlenecek yol hususunda görüşmeler yapılmıştır.
17 Ocak 2023

COST Programı’nın ''CA19102 - Language in the Human-Machine Era aksiyonuna Çalışma Grubu Üyesi (WG)'' olarak atanmıştır.
17 Ocak 2023

TÜBİTAK 1005-Ulusal Yeni Fikirler ve Ürünler Araştırma Destek Programı kapsamında desteklenmeye hak kazanmıştır.
17 Ocak 2023

Projesi “Türkiye Sağlık Enstitüleri Başkanlığı (TÜSEB) Acil Araştırma ve Geliştirme Projelerini Destekleme Programı B Grubu Ar-Ge Proje Çağrısı” kapsamında desteklenmiştir.
17 Ocak 2023

Projesi “Türkiye Sağlık Enstitüleri Başkanlığı (TÜSEB) Acil Araştırma ve Geliştirme Projelerini Destekleme Programı B Grubu Ar-Ge Proje Çağrısı” kapsamında desteklenmiştir.
17 Ocak 2023

Oyak Renault Otomobil Fabrikaları A.Ş. firması ile çevrim içi tanışma toplantısı düzenlendi.
12 Ocak 2023

“CA21101 - Confined Molecular Systems: From a New Generation of Materials to the Stars (COSY)'' aksiyonuna Çalışma Grubu Üyesi (WG)” olarak atanmıştır.
11 Ocak 2023

''CA19102 - Language in the Human-Machine Era''
10 Ocak 2023

''Otonom İnsansız Su üstü Aracı Kullanarak Sucul Ekosistemleri Etkileyen Faktörlerin Ölçülmesi ve İzlenmesi''
09 Ocak 2023

''Deniz Araçlarının Alt Kısımlarını Temizleyen Otonom Su Altı Robotu''
09 Ocak 2023

''Deniz Dibi Temizleme ve Destek Robotu''
09 Ocak 2023

COST Programına Çalışma Grubu Üyesi (WG)
06 Ocak 2023

2022 Aralık Ayı Bülteni
06 Ocak 2023

Harita Mühendisliği’ne Bölüm Ziyareti
05 Ocak 2023

COST Programına Çalışma Grubu Üyesi (WG)
05 Ocak 2023

COST Programına Çalışma Grubu Üyesi (WG)
05 Ocak 2023

TĂśBÄ°TAK Proje DesteÄźi
04 Ocak 2023

TĂśBÄ°TAK Proje DesteÄźi
04 Ocak 2023

COST Programına Çalışma Grubu Üyesi (WG)
04 Ocak 2023

Teknoloji Girişimciliği ve Girişimcilik Yol Haritası Eğitimi
04 Ocak 2023

TÜBİTAK 1512 BİGG Programı
04 Ocak 2023

COST Programına Çalışma Grubu Üyesi (WG)
03 Ocak 2023

estek Programları Bilgilendirme Etkinliği
03 Ocak 2023

COST Programına Çalışma Grubu Üyesi (WG)
03 Ocak 2023

TĂśBÄ°TAK Proje DesteÄźi
02 Ocak 2023

TĂśBÄ°TAK Proje DesteÄźi
02 Ocak 2023

COST Programına Çalışma Grubu Üyesi (WG)
02 Ocak 2023

COST Programına Çalışma Grubu Üyesi (WG)
30 Aralık 2022

COST Programına Çalışma Grubu Üyesi (WG)
30 Aralık 2022

TÜBİTAK 1001 Programı 2022/2. Dönem Başvuru Sonuçları
29 Aralık 2022

COST Programına Çalışma Grubu Üyesi (WG)
29 Aralık 2022

COST Programına Çalışma Grubu Üyesi (WG)
29 Aralık 2022

COST Programına Çalışma Grubu Üyesi (WG)
29 Aralık 2022

COST Programına Çalışma Grubu Üyesi (WG)
28 Aralık 2022

COST Programına Çalışma Grubu Üyesi (WG)
28 Aralık 2022

Bilgi GĂĽnĂĽ
27 Aralık 2022

COST Programına Çalışma Grubu Üyesi (WG)
27 Aralık 2022

COST Programına Çalışma Grubu Üyesi (WG)
26 Aralık 2022

TĂśBÄ°TAK 2519 Proje DesteÄźi
26 Aralık 2022

COST Programına Çalışma Grubu Üyesi (WG)
23 Aralık 2022

Avrupa Patent Akademisi 2023 EÄźitim KataloÄźu
23 Aralık 2022

TÜBİTAK 1512 BİGG Programı
20 Aralık 2022

Patent ve Faydalı Model Tescil Töreni
22 Aralık 2022

TĂśBÄ°TAK Proje DesteÄźi
22 Aralık 2022

COST Programına Çalışma Grubu Üyesi (WG)
22 Aralık 2022

TĂśBÄ°TAK Proje DesteÄźi
21 Aralık 2022

Patent Araştırması ve Girişimcilik Eğitimi
20 Aralık 2022

Maden Türkiye 2022 Fuarı
20 Aralık 2022

COST Programına Çalışma Grubu Üyesi (WG)
20 Aralık 2022

COST Programına Çalışma Grubu Üyesi (WG)
19 Aralık 2022

Anti_Grayonotoksin Özgül Antikorların Üretilmesi ve Grayonotoksinin İmmünolojik Olarak Ölçülmesi
16 Aralık 2022

Sanayi ve Teknoloji İş Birliği Kurulu (SANTEK) Toplantısı
16 Aralık 2022

COST Programına Çalışma Grubu Üyesi (WG)
15 Aralık 2022

Türkiye İnovasyon Haftası
14 Aralık 2022

COST Programına Çalışma Grubu Üyesi (WG)
13 Aralık 2022

Ăśniversite Sanayi Ä°ĹźbirliÄźi Faaliyetleri
13 Aralık 2022

TÜBİTAK 2242 Üniversite Öğrencileri Araştırma Proje Yarışmaları
13 Aralık 2022

CA19102 - Language in the Human-Machine Era
12 Aralık 2022

Ulusal ve Uluslararası Programlar Hakkında Bilgilendirme
09 Aralık 2022

Ăśniversite Sanayi Ä°Ĺź BirliÄźi
08 Aralık 2022

COST Programına Çalışma Grubu Üyesi (WG)
08 Aralık 2022

Proje Hazırlama Eğitimi
08 Aralık 2022

SMART Youth Projesi
08 Aralık 2022

Kasım Ayı Bülteni (85. Sayı)
07 Aralık 2022

COST Programına Çalışma Grubu Üyesi (WG)
07 Aralık 2022

Startup Reach Out etkinliÄźi
07 Aralık 2022

LIFT UP++ Sanayi Odaklı Doktora Araştırmaları
07 Aralık 2022

Trabzon Ticaret ve Sanayi Odası'na ZiyaretÂ
06 Aralık 2022

Arsin Organize Sanayi Bölgesi
06 Aralık 2022

COST Programına Çalışma Grubu Üyesi (WG)
06 Aralık 2022

COST Programına Çalışma Grubu Üyesi (WG)
05 Aralık 2022

2020-2022 yılları arasında yürütülmüş, başarıyla tamamlanan projenin sonuç ve çıktıları hedef kitleyle paylaşılma aşamasına gelinmiştir.
02 Aralık 2022

Dr. Öğr. Üyesi Aysel ÖZSABAN, COST Programı'nın ''CA21137-Ethics in Dementia (EDEM)'' aksiyonuna Çalışma Grubu Üyesi (WG) olarak atanmıştır.
02 Aralık 2022

"Asprosinin Hipotalamo-Hipofizer-Adrenal Aksa Etkilerinin Araştırılması" başlıklı projesi TÜBİTAK 1002-A ''Hızlı Destek Modülü Programı'' kapsamında desteklenmiştir.
02 Aralık 2022

Arş. Gör. Aysun BAYRAM, COST Programı'nın ''CA21137 - Ethics in Dementia (EDEM)'' aksiyonuna Çalışma Grubu Üyesi (WG) olarak atanmıştır.
01 Aralık 2022

Projesi TÜBİTAK 1002-B ''Acil Destek Modülü Programı'' kapsamında desteklenmiştir.
01 Aralık 2022

Vezirköprü Orman Ürünleri ve Kağıt San. A.Ş. firması ofisimize davet edildi
30 Kasım 2022

Doktora Öğrencisi Hilal FAZLI, COST Programı’nın “CA21126 - Carbon molecular nanostructures in space (NanoSpace)” aksiyonuna Çalışma Grubu Üyesi (WG) olarak atanmıştır.
30 Kasım 2022

Dr. Öğr. Üyesi Ali Şükrü ÖZBAY, COST Programı’nın “CA19102 - Language in the Human-Machine Era’’ aksiyonuna Çalışma Grubu Üyesi (WG) olarak atanmıştır.
30 Kasım 2022

"Eklemeli İmalat ile Üretilen Titanyum Alaşımının Servis Performansının Özgün İkincil Yüzey İşlemleriyle İyileştirilmesi" başlıklı proje
29 Kasım 2022

Dr. Ă–Äźr. Ăśyesi UÄźur UZUNER'in "A Herbal Composition Comprising Antifungal Protein Derivatives" isimli Uluslararası Patent baĹźvurusu tescillenmiĹźtir.Â
29 Kasım 2022

Prof. Dr. Sevgi KOLAYLI'nın ''Ekolojik Propolis Özüt ve Kapsüllerinin Geliştirilmesi" başlıklı projesi TÜBİTAK 1505–''Üniversite-Sanayi İş Birliği Programı''kapsamında desteklendi
29 Kasım 2022

TÜBİTAK 1002-Hızlı Destek Programı
28 Kasım 2022

TÜBİTAK 1002-Hızlı Destek Programı
28 Kasım 2022

Proje DesteÄźi
25 Kasım 2022

COST Programına Çalışma Grubu Üyesi (WG)
25 Kasım 2022

KTÜ TTM 2022 Yılı Dış Paydaş ve İç Paydaş Toplantıları
25 Kasım 2022

Ăśniversite Sanayi Ä°ĹźbirliÄźi Faaliyetleri
25 Kasım 2022

Ăśniversite Sanayi Ä°ĹźbirliÄźi Faaliyetleri
25 Kasım 2022

USİMP Patent Fuarı
24 Kasım 2022

COST Programına Çalışma Grubu Üyesi (WG)
24 Kasım 2022

Akademisyenlerimizin katıldıkları programa dair süreçler ve tecrübeleri
23 Kasım 2022

Bilimsel Araştırma Projesi Hazırlama Eğitimi
23 Kasım 2022

TĂśBÄ°TAK 2237 Proje EÄźitimi
23 Kasım 2022

COST Programına Yönetim Komitesi Üyesi (MC)
23 Kasım 2022

COST Programına Çalışma Grubu Üyesi
23 Kasım 2022

Patent BaĹźvurusu ve Proje
22 Kasım 2022

KTÜ TTM web sayfası yayınlar bölümünde yer almaktadır.
22 Kasım 2022

Dünya Kadın Girişimciler Günü
21 Kasım 2022

COST Programı Çalışma Grubu Üyesi (WG)
21 Kasım 2022

COST Programına Çalışma Grubu Üyesi
18 Kasım 2022

TĂśBÄ°TAK 2209-A / TĂśBÄ°TAK 2209-B
17 Kasım 2022

SMART Youth Projesi
17 Kasım 2022

TÜBİTAK – MESU (Ukrayna) İkili İş Birliği Proje Desteği
17 Kasım 2022

Ar-Ge Maraton Hızlandırma Programı
17 Kasım 2022

Ăśniversite Sanayi Ä°ĹźbirliÄźi Faaliyetleri
15 Kasım 2022

COST Programına Çalışma Grubu Üyesi (WG)
15 Kasım 2022

COST Programına Çalışma Grubu Üyesi (WG)
15 Kasım 2022

COST Programına Çalışma Grubu Üyesi (WG)
14 Kasım 2022

COST Programına Çalışma Grubu Üyesi (WG)
14 Kasım 2022

''Strategic Management, Agility and Right Technologies for Youth''
11 Kasım 2022

Ăśniversite Sanayi Ä°ĹźbirliÄźi
11 Kasım 2022

Ăśniversite Sanayi Ä°ĹźbirliÄźi
11 Kasım 2022

GiriĹźimcilik EÄźitimi
11 Kasım 2022

TÜBİTAK 2209 Programlarının başvuru koşullarının ve detaylarının yanı sıra faydalanabilecekleri diğer programlarında detayları paylaşılmıştır.
10 Kasım 2022

TÜBİTAK Lisans Öğrencilerine Yönelik Burs Programları Bilgilendirme Semineri
10 Kasım 2022

CA21160 - Non-globular proteins in the era of Machine Learning (ML4NGP)
10 Kasım 2022

COST Programına Çalışma Grubu Üyesi
09 Kasım 2022

Erasmus+ Programı Kapsamında SMART Youth Projesi Kapanış Toplantısı - 9 Kasım 2022
02 Kasım 2022

Girişimcilere Dijitalleşme Becerileri Kazandırmayı Amaçlayan Eğitim Müfredatı
31 Ekim 2022

SAHA EXPO 2022 Savunma Havacılık ve Uzay Sanayi Fuarı
31 Ekim 2022

TÜBİTAK BİDEB Burs ve Destek Programları Bilgi Günü
31 Ekim 2022

Öğrencilerine Yönelik Bilgi Günü Düzenlendi
27 Ekim 2022

TÜBİTAK BİDEB 2244 Sanayi Doktora Programı
27 Ekim 2022

Vaka Analizi EtkinliÄźi
26 Ekim 2022

Arş. Gör. Dr. Arif Kamil SALİHOĞLU
24 Ekim 2022

TĂśBÄ°TAK 3501 Proje DesteÄźi
21 Ekim 2022

TĂśBÄ°TAK 3501 Proje DesteÄźi
21 Ekim 2022

Ăśniversite Sanayi Ä°ĹźbirliÄźi Faaliyetleri
19 Ekim 2022

Ăśniversite Sanayi Ä°ĹźbirliÄźi Faaliyetleri
18 Ekim 2022

Mühendislik Fakültesi 1. Öğrenci Buluşması Etkinliği
14 Ekim 2022

TÜRKONFED ve İş Bankası temsilcileri ile bir araya gelinerek olası işbirlikleri hakkında görüşme sağlandı.
12 Ekim 2022

KTÜ Moleküler Biyoloji ve Genetik Bölümü lisans öğrencilerine yönelik olarak düzenlenmiştir.
11 Ekim 2022

Etkinlikte TÜBİTAK 2209 Programlarının başvuru koşullarının ve detaylarının yanı sıra, lisans öğrencilerinin faydalanabilecekleri diğer programların da detayları paylaşılmıştır.
11 Ekim 2022

KTÜ TTM'nin Yürütücüsü Olduğu Erasmus+ Projesi Kapsamında Düzenlenen Sanal Eğitim Kampı, 4 Farklı Ülkeden Katılım ile Başarıyla Tamamlandı
10 Ekim 2022

Üniversite Sanayi İş Birliği Faaliyetleri Kapsamında Firma Görüşmeleri Devam Ediyor!
10 Ekim 2022

Prof. Dr. Tamer TÜZÜNER COST Programına Çalışma Grubu Üyesi (WG) Olarak Atandı
07 Ekim 2022

Ulusal Patent ve Faydalı Model Başvuruları Tescillenen Akademisyenlerimiz ve Buluşculaımızı Tebrik Ederiz
07 Ekim 2022

Girişimcimize TÜBİTAK 1512 Programı Kapsamında Proje Desteği
06 Ekim 2022

Akademisyenimize TÜBİTAK 1512 Programı Kapsamında Proje Desteği
06 Ekim 2022

KTĂś TTMÂ’den Recep Tayyip ErdoÄźan ĂśniversitesiÂ’ne ve RTEĂś TTOÂ’ya Ziyaret!
05 Ekim 2022

Ăśniversite Sanayi Ä°Ĺź BirliÄźi SĂĽrecinde EĹźleĹźtirme Faaliyetleri Devam Ediyor!
05 Ekim 2022

Akademisyenimize TÜBİTAK 1002-A Hızlı Destek Modülü Kapsamında Proje Desteği
04 Ekim 2022

Patent Knowledge Week, Online Etkinlik, 4 -7 Ekim 2022
03 Ekim 2022

Dr. Öğr. Üyesi Cihan İNAN COST Programına Çalışma Grubu Üyesi (WG) Olarak Atandı
03 Ekim 2022

Akademisyenimize TÜBİTAK – ARRS (Slovenya) İkili İş Birliği Proje Desteği
30 EylĂĽl 2022

Akademisyenimize TĂśBÄ°TAK 3501 Proje DesteÄźi
30 EylĂĽl 2022

Akademisyenimize Erasmus+ KA2 Okul Eğitiminde İş Birliği Ortaklıkları (KA220-SCH) Proje Desteği
29 EylĂĽl 2022

Üniversite Sanayi İşbirliği Faaliyetleri Kapsamında Proje Hazırlık Çalışmaları Ediyor!
29 EylĂĽl 2022

BİDEB 2244-Sanayi Doktora Programı Kapsamında Firma-Akademisyen İşbirlikleri Devam Ediyor!
28 EylĂĽl 2022

Doç. Dr. Derya USTAÖMER COST Programına Çalışma Grubu Üyesi (WG) Olarak Atandı
28 EylĂĽl 2022

Prof. Dr. Ayfer DÖNMEZ ÇAVDAR COST Programına Çalışma Grubu Üyesi (WG) Olarak Atandı
28 EylĂĽl 2022

KTÜ TTM'nin Yürütmüş Olduğu Erasmus+ Projesi Kapsamında Yeni Nesil Girişimciler İçin "Kriz Yönetimi Deneyimleri ve İyi Uygulama Örnekleri Video Serisi" Yayında!
27 EylĂĽl 2022

Akademisyenimize Erasmus+ KA2 Okul Eğitiminde İş Birliği Ortaklıkları (KA220-SCH) Proje Desteği
27 EylĂĽl 2022

Doç. Dr. Serap DURMUŞ ÖZTÜRK COST Programına Çalışma Grubu Üyesi (WG) Olarak Atandı
27 EylĂĽl 2022

TOBB Trabzon İl Kadın Girişimciler Kurulu Aylık Toplantısı Gerçekleştirildi
22 EylĂĽl 2022

TÜBİTAK "BİDEB 2237 Programı” kapsamında 2022 yılı 2. Dönemi’nde Üniversitemizden 3 proje önerisi desteklenmeye hak kazanmıştır.
20 EylĂĽl 2022

Akademisyenimize TĂśBÄ°TAK 3005 Proje DesteÄźi
20 EylĂĽl 2022

Üniversite Sanayi İş Birliği Faaliyetleri Kapsamında Firma Görüşmeleri Devam Ediyor
16 EylĂĽl 2022

Üniversite Sanayi İşbirliği Faaliyetleri Kapsamında Firma Görüşmeleri Devam Ediyor!
14 EylĂĽl 2022

TÜSEB A Grubu Acil Ar-Ge Proje Destek Programı
14 EylĂĽl 2022

Üniversitemiz Araştırma Ekibi “The Varieties of English for Specific Purposes Database (VESPA)” İsimli Uluslararası Proje Konsorsiyumunda Ülkemizi Temsil Edecek
14 EylĂĽl 2022

Akademisyenimize TĂśBÄ°TAK 1001 Proje DesteÄźi
13 EylĂĽl 2022

SMART Youth Projesi Kapsamında Sanal Eğitim Kampları'nın İkinci Oturumu 13-15 Eylül'de Gerçekleşecek
12 EylĂĽl 2022

Bu Yıl Beşincisi Düzenlenen Dünyanın En Büyük Havacılık, Uzay ve Teknoloji Festivali TEKNOFEST 4 Eylül’de Samsun’da Tamamlandı
16 EylĂĽl 2022

Prof. Dr. Kemal TURHAN COST Programına Yönetim Komitesi Üyesi (MC) Olarak Atandı
12 EylĂĽl 2022

Arş. Gör. Hazel Ceren ERKENGEL COST Programına Çalışma Grubu Üyesi (WG) Olarak Atandı
09 EylĂĽl 2022

SMART Youth Projesi Kapsamında Sanal Eğitim Kampları 31 Ağustos'ta Başlıyor!
29 AÄźustos 2022

KTÜ TTM Doğu Karadeniz Girişim Hızlandırma Programı-22’de Yatırımcı Görüşmeleri Tamamlandı
22 AÄźustos 2022

Prof. Dr. Kemal TURHAN COST Programına Yönetim Komitesi Üyesi (MC) Olarak Atandı
19 AÄźustos 2022

Akademisyenimize TÜSEB Acil AR-GE Projelerini Destekleme Programı Proje Desteği
17 AÄźustos 2022

Doğu Karadeniz Girişim Hızlandırma Programı 22 - Demoday Etkinliği
15 AÄźustos 2022

Üniversitemiz Araştırmacılarından Üniversite Sanayi İş Birliğine Katkı
10 AÄźustos 2022

Arş. Gör. Nurhayat KORKMAZ COST Programına Çalışma Grubu Üyesi (WG) Olarak Atandı
10 AÄźustos 2022

TÜBİTAK 2244-Sanayi Doktora Programı Burs Miktarları Güncellendi
01 AÄźustos 2022

Dr.Öğr.Üyesi Ekrem BAHÇEKAPILI COST Programına Yönetim Komitesi Üyesi (MC) Olarak Atandı
29 Temmuz 2022

SMART Youth Projesi Kapsamında Sanal Eğitim Kampları Düzenlenecektir !!!
28 Temmuz 2022

KTÜ-TİSAŞ Ortaklığında Yürütülen TÜBİTAK 2244 Sanayi Doktora Programı Kapsamında Dönem Değerlendirme Toplantısı Gerçekleştirildi !
27 Temmuz 2022

TÜBİTAK 1001 Programı 2022/1. Dönem Başvuru Sonuçları Açıklandı!
08 Temmuz 2022

Akademisyenimize TÜSEB AR-GE Projelerini Destekleme Programı 2022-EKG-01 Çağrısı Kapsamında Proje Desteği
08 Temmuz 2022

Dr. Öğr. Üyesi UMAR KHAN DURRANI COST Programına Çalışma Grubu Üyesi (WG) Olarak Atandı
05 Temmuz 2022

SMART Youth Projesi Kapsamında Eğiticilerin Eğitimi Faaliyeti İrlanda’da Gerçekleştirildi
05 Temmuz 2022

Üniversitemiz Teknoloji Transfer Ofisi'nin yürüttüğü 450.000 TL hibe fırsatı sunan TÜBİTAK 1512 BİGG Programı'nın 2022 yılı 2. çağrısı, "Yeşil Büyüme" temasıyla açıldı!
04 Temmuz 2022

Arş. Gör. Dr. Arif Kamil SALİHOĞLU COST Programına Çalışma Grubu Üyesi (WG) Olarak Atandı
07 Temmuz 2022

TÜBİTAK 1005 ve 3501 Programlarının Bütçe Üst Limitleri Artırıldı
04 Temmuz 2022

Akademisyenimize TĂśBÄ°TAK Proje DesteÄźi
07 Temmuz 2022

Akademisyenimize TĂśBÄ°TAK Proje DesteÄźi
07 Temmuz 2022

Dr. Öğr. Üyesi Beste ÜSTÜBİOĞLU COST Programına Çalışma Grubu Üyesi (WG) Olarak Atandı
07 Temmuz 2022

Arş. Gör. Kübra SAĞLAM COST Programına Çalışma Grubu Üyesi (WG) Olarak Atandı
07 Temmuz 2022

Herhangi Bir Kurum/Kuruluşta Çalışmayan Doktoralı Araştırmacılara TÜBİTAK Projelerinde Yürütücü Olabilme İmkânı
07 Temmuz 2022

TÜBİTAK 1002 Programında Büyük Yenilikler
07 Temmuz 2022

Üniversitemiz Akademisyenlerinden Önemli Başarı
07 Temmuz 2022

Doktora Öğrencisi Hilal FAZLI COST Programına Çalışma Grubu Üyesi (WG) Olarak Atandı
07 Temmuz 2022

Dr. Öğr. Üyesi Uğur UZUNER COST Programına, Çalışma Grubu Üyesi (WG) Olarak Atandı
07 Temmuz 2022

Dr. Öğr. Üyesi Zeynep HASIRCI TUĞCU COST Programına Çalışma Grubu Üyesi (WG) Olarak Atandı
07 Temmuz 2022

SMART Youth Projesi Kapsamında ''Çözüm Sağlayıcıları Veritabanı'' Oluşturuldu
06 Temmuz 2022

"15. Düşünden Gerçeğine Proje Pazarı" Etkinliği Tamamlandı!
06 Temmuz 2022

Dr. Öğr. Üyesi Ekrem BAHÇEKAPILI COST Programına Çalışma Grubu Üyesi (WG) Olarak Atandı
06 Temmuz 2022

Arş. Gör. Cansu BEŞEL COST Programına Çalışma Grubu Üyesi (WG) Olarak Atandı
06 Temmuz 2022

KTÜ Mühendislik Fakültesi Lisans öğrencilerine Yönelik “Proje Hazırlama Eğitimi” Düzenlendi
06 Temmuz 2022

70 Yeni COST Aksiyonu YĂĽrĂĽrlĂĽÄźe Girdi!
06 Temmuz 2022

KTÜ Yönetim ve Bilişim Sistemleri Bölümü’ne Girişimcilik Eğitimi Gerçekleştirildi
06 Temmuz 2022

KTÜ TTM İstanbul’da Gerçekleştirilen 4. Savunma Sanayii Buluşmaları’nda Yerini Aldı!
06 Temmuz 2022

2021 Türkiye Patent Raporu Yayınlandı!
06 Temmuz 2022

Üniversitemiz Eczacılık Fakültesi Öğretim Üyelerimizden Prof. Dr. Oktay YILDIZ'dan 3 Sanayi Projesi Başarısı
06 Temmuz 2022

KTÜ Olarak Ulusal Bor Araştırma Enstitüsü (BOREN) ve Eti Maden İşletmeleri Genel Müdürlüğü'ne Akademik Odak Grup Ziyareti Düzenlendi
06 Temmuz 2022

Üniversitemiz Teknoloji Transferi Uygulama ve Araştırma Merkezi TÜBİTAK 1513 Programı Kapsamında Destek Almaya Hak Kazandı
18 Mayıs 2022

TÜBİTAK 2209-A kapsamında 68, TÜBİTAK 2209-B kapsamında 16 KTÜ Lisans öğrencisi destek almaya hak kazanmıştır.
18 Mayıs 2022

Trabzon TEKNOKENT’te, 11-13 Mayıs 2022 tarihleri arasında "Teknokentlerde Yer Alan/Almak İsteyen Akademisyenlere Yönelik Ar-Ge Projesi Hazırlama Eğitimi” etkinliği düzenlendi.
16 Mayıs 2022

KTÜ Rektör Yardımcısı Prof. Dr. Halil İbrahim OKUMUŞ ve KTÜ Teknoloji Transfer Merkezi Müdürü Prof. Dr. Oktay Yıldız tarafından KTÜ bünyesindeki öğrenci toplulukları ziyaret edilerek me
16 Mayıs 2022

13 Mayıs 2022

11 Mayıs 2022

11 Mayıs 2022

09 Mayıs 2022

Günümüz Dijital Dünyasında ve Özellikle Pandemi Gibi Kriz Dönemleri Özelinde İhtiyaç Duyulan Girişimcilik Becerileri Üzerine Araştırma Raporu Yayınlandı!
09 Mayıs 2022

Proje Yürütücüsü: Dr. Öğr. Üyesi Özgür AYDIN Mühendislik Fakültesi Makine Mühendisliği Bölümü
29 Nisan 2022

Proje Yürütücüsü: Prof. Dr. Faruk AYDIN Mühendislik Fakültesi, Jeoloji Mühendisliği Bölümü
29 Nisan 2022

27 Nisan 2022

Akademisyenimize TĂśBÄ°TAK Proje DesteÄźi
26 Nisan 2022

14 Nisan 2022

13 Nisan 2022

12 Nisan 2022

12 Nisan 2022

08 Nisan 2022

06 Nisan 2022

05 Nisan 2022

04 Nisan 2022

04 Nisan 2022

01 Nisan 2022

31 Mart 2022

31 Mart 2022

30 Mart 2022

28 Mart 2022

25 Mart 2022

25 Mart 2022

25 Mart 2022

23 Mart 2022

22 Mart 2022

22 Mart 2022

22 Mart 2022

16 Mart 2022

15 Mart 2022

14 Mart 2022

11 Mart 2022

11 Mart 2022

11 Mart 2022

09 Mart 2022

09 Mart 2022

07 Mart 2022

02 Mart 2022

02 Mart 2022

01 Mart 2022

01 Mart 2022

24 Ĺžubat 2022

23 Ĺžubat 2022

21 Ĺžubat 2022

16 Ĺžubat 2022

16 Ĺžubat 2022

15 Ĺžubat 2022

2022 Yılı Düşünden Gerçeğine Proje Pazarı Etkinliğine Başvuru
22 Aralık 2021

Ufuk Avrupa Programı 2022 Yılı Çağrı Programlarını İnceleyerek Geleceğe Yönelik Proje Çalışmalarınızı Başlatabilirsiniz
26 Kasım 2021

Ufuk Avrupa ile 2021-2027 yılları arasında 95,5 milyar Avro'luk bütçeyle bilim ve yenilik faaliyetlerinin desteklenmesi hedeflenmektedir.
30 Haziran 2021

09 Ĺžubat 2022

07 Ĺžubat 2022

07 Ĺžubat 2022

04 Ĺžubat 2022

04 Ĺžubat 2022

04 Ĺžubat 2022

04 Ĺžubat 2022

31 Ocak 2022

28 Ocak 2022

28 Ocak 2022

27 Ocak 2022

26 Ocak 2022

26 Ocak 2022

26 Ocak 2022

21 Ocak 2022

21 Ocak 2022

18 Ocak 2022

18 Ocak 2022

17 Ocak 2022

13 Ocak 2022

12 Ocak 2022

11 Ocak 2022

11 Ocak 2022

10 Ocak 2022

29 Aralık 2021

29 Aralık 2021

28 Aralık 2021

27 Aralık 2021

24 Aralık 2021

24 Aralık 2021

24 Aralık 2021

24 Aralık 2021

24 Aralık 2021

24 Aralık 2021

24 Aralık 2021

22 Aralık 2021

22 Aralık 2021

20 Aralık 2021

20 Aralık 2021

16 Aralık 2021

16 Aralık 2021

15 Aralık 2021

14 Aralık 2021

14 Aralık 2021

09 Aralık 2021

08 Aralık 2021

07 Aralık 2021

07 Aralık 2021

02 Aralık 2021

01 Aralık 2021

26 Kasım 2021

26 Kasım 2021

25 Kasım 2021

22 Kasım 2021

22 Kasım 2021

22 Kasım 2021

17 Kasım 2021

17 Kasım 2021

17 Kasım 2021

16 Kasım 2021

15 Kasım 2021

12 Kasım 2021

12 Kasım 2021

10 Kasım 2021

10 Kasım 2021

08 Kasım 2021

08 Kasım 2021

04 Kasım 2021

02 Kasım 2021

02 Kasım 2021

01 Kasım 2021

28 Ekim 2021

28 Ekim 2021

27 Ekim 2021

26 Ekim 2021

26 Ekim 2021

25 Ekim 2021

21 Ekim 2021

21 Ekim 2021

21 Ekim 2021

18 Ekim 2021

15 Ekim 2021

15 Ekim 2021

13 Ekim 2021

13 Ekim 2021

11 Ekim 2021

08 Ekim 2021

07 Ekim 2021

07 Ekim 2021

06 Ekim 2021

06 Ekim 2021

05 Ekim 2021

04 Ekim 2021

04 Ekim 2021

04 Ekim 2021

04 Ekim 2021

01 Ekim 2021

01 Ekim 2021

30 EylĂĽl 2021

30 EylĂĽl 2021

29 EylĂĽl 2021

29 EylĂĽl 2021

23 EylĂĽl 2021

27 EylĂĽl 2021

27 EylĂĽl 2021

20 EylĂĽl 2021

14 EylĂĽl 2021

14 EylĂĽl 2021

20 EylĂĽl 2021

20 EylĂĽl 2021

17 EylĂĽl 2021

16 EylĂĽl 2021

16 EylĂĽl 2021

15 EylĂĽl 2021

15 EylĂĽl 2021

13 EylĂĽl 2021

08 EylĂĽl 2021

06 EylĂĽl 2021

03 EylĂĽl 2021

02 EylĂĽl 2021

01 EylĂĽl 2021

26 AÄźustos 2021

24 AÄźustos 2021

16 AÄźustos 2021

16 AÄźustos 2021

13 AÄźustos 2021

09 AÄźustos 2021

09 AÄźustos 2021

09 AÄźustos 2021

06 AÄźustos 2021

06 AÄźustos 2021

02 AÄźustos 2021

02 AÄźustos 2021

02 AÄźustos 2021

02 AÄźustos 2021

26 Temmuz 2021

26 Temmuz 2021

14 Temmuz 2021

12 Temmuz 2021

13 Temmuz 2021

09 Temmuz 2021

09 Temmuz 2021

08 Temmuz 2021

08 Temmuz 2021

02 Temmuz 2021

01 Temmuz 2021

30 Haziran 2021

30 Haziran 2021

29 Haziran 2021

28 Haziran 2021

25 Haziran 2021

25 Haziran 2021

24 Haziran 2021

23 Haziran 2021

18 Haziran 2021

15 Haziran 2021

10 Haziran 2021

04 Haziran 2021

04 Haziran 2021

02 Haziran 2021

02 Haziran 2021

01 Haziran 2021

26 Mayıs 2021

25 Mayıs 2021

25 Mayıs 2021

20 Mayıs 2021

17 Mayıs 2021

17 Mayıs 2021

03 Mayıs 2021

30 Nisan 2021

20 Mayıs 2021

28 Nisan 2021

21 Nisan 2021

20 Nisan 2021

13 Nisan 2021

13 Nisan 2021

12 Nisan 2021

12 Nisan 2021

09 Nisan 2021

09 Nisan 2021

07 Nisan 2021

06 Nisan 2021

05 Nisan 2021

01 Nisan 2021

31 Mart 2021

31 Mart 2021

30 Mart 2021

29 Mart 2021

26 Mart 2021

25 Mart 2021

23 Mart 2021

22 Mart 2021

15 Mart 2021

12 Mart 2021

10 Mart 2021

09 Mart 2021

05 Mart 2021

05 Mart 2021

04 Mart 2021

04 Mart 2021

03 Mart 2021

01 Mart 2021

26 Ĺžubat 2021

25 Ĺžubat 2021

23 Ĺžubat 2021

23 Ĺžubat 2021

19 Ĺžubat 2021

17 Ĺžubat 2021

16 Ĺžubat 2021

11 Ĺžubat 2021

10 Ĺžubat 2021

08 Ĺžubat 2021

05 Ĺžubat 2021

05 Ĺžubat 2021

05 Ĺžubat 2021

03 Ĺžubat 2021

02 Ĺžubat 2021

27 Ocak 2021

26 Ocak 2021

22 Ocak 2021

22 Ocak 2021

22 Ocak 2021

19 Ocak 2021

15 Ocak 2021

15 Ocak 2021

13 Ocak 2021

13 Ocak 2021

12 Ocak 2021

13 Ocak 2021

11 Ocak 2021

11 Ocak 2021

06 Ocak 2021

05 Ocak 2021

04 Ocak 2021

31 Aralık 2020

31 Aralık 2020

31 Aralık 2020

29 Aralık 2020

23 Aralık 2020

23 Aralık 2020

23 Aralık 2020

18 Aralık 2020

17 Aralık 2020

16 Aralık 2020

Patent Yazma
28 Kasım 2020

14 Aralık 2020

14 Aralık 2020

14 Aralık 2020

10 Aralık 2020

09 Aralık 2020

09 Aralık 2020

09 Aralık 2020

08 Aralık 2020

08 Aralık 2020

07 Aralık 2020

04 Aralık 2020

03 Aralık 2020

03 Aralık 2020

02 Aralık 2020

27 Kasım 2020

27 Kasım 2020

26 Kasım 2020

25 Kasım 2020

24 Kasım 2020

23 Kasım 2020

23 Kasım 2020

20 Kasım 2020

20 Kasım 2020

20 Kasım 2020

20 Kasım 2020

18 Kasım 2020

17 Kasım 2020

16 Kasım 2020

16 Kasım 2020

11 Kasım 2020

10 Kasım 2020

09 Kasım 2020

09 Kasım 2020

06 Kasım 2020

04 Kasım 2020

04 Kasım 2020

03 Kasım 2020

02 Kasım 2020

27 Ekim 2020

27 Ekim 2020

26 Ekim 2020

26 Ekim 2020

22 Ekim 2020

21 Ekim 2020

21 Ekim 2020

21 Ekim 2020

19 Ekim 2020

19 Ekim 2020

19 Ekim 2020

16 Ekim 2020

16 Ekim 2020

15 Ekim 2020

15 Ekim 2020

13 Ekim 2020

13 Ekim 2020

13 Ekim 2020

08 Ekim 2020

07 Ekim 2020

07 Ekim 2020

07 Ekim 2020

07 Ekim 2020

06 Ekim 2020

06 Ekim 2020

05 Ekim 2020

05 Ekim 2020

30 EylĂĽl 2020

28 EylĂĽl 2020

18 EylĂĽl 2020

17 EylĂĽl 2020

14 EylĂĽl 2020

10 EylĂĽl 2020

31 AÄźustos 2020

31 AÄźustos 2020

28 AÄźustos 2020

25 AÄźustos 2020
24 AÄźustos 2020

24 AÄźustos 2020

19 AÄźustos 2020

19 AÄźustos 2020

17 AÄźustos 2020

10 AÄźustos 2020

07 AÄźustos 2020

29 Temmuz 2020

22 Temmuz 2020

14 Temmuz 2020

10 Temmuz 2020

10 Temmuz 2020

10 Temmuz 2020

30 Kasım -0001

08 Temmuz 2020

07 Temmuz 2020

06 Temmuz 2020

03 Temmuz 2020

01 Temmuz 2020

30 Haziran 2020

30 Haziran 2020

30 Haziran 2020

30 Haziran 2020

26 Haziran 2020

25 Haziran 2020

23 Haziran 2020

22 Haziran 2020

22 Haziran 2020

19 Haziran 2020

19 Haziran 2020

15 Haziran 2020

08 Haziran 2020

05 Haziran 2020

03 Haziran 2020

02 Haziran 2020

27 Mayıs 2020

26 Mayıs 2020

03 Haziran 2020

22 Nisan 2020

22 Nisan 2020

22 Nisan 2020

12 Mart 2020

24 Ĺžubat 2020

21 Ĺžubat 2020

13 Ĺžubat 2020

13 Ĺžubat 2020

13 Ĺžubat 2020

13 Ĺžubat 2020
